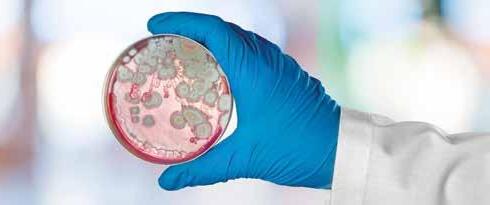

![]()









La porzionatrice intelligente
La taglierina perfetta per porzionare a peso fsso carni fresche senz’osso. Precisione ineguagliabile su tagli di manzo di alta qualità. Taglio netto, pulitissimo, anche in presenza di grasso. Divide in fette, tranci o porzioni, programmabile in pochi secondi.



Direttore responsabile:
Cristina Filetti
Direttore CommerCiale:
Luca Codato - codato@ecod.it
reDazione: Marina Caccialanza - redazione@ecod.it
GrafiC a e impaGinazione: Sabrina Zampini - grafica@ecod.it
Hanno Collaborato:
Chiara Di Paola; Angela Mucciolo; Claudio Mucciolo; Giuseppe L. Pastori.
Il contenuto della rivista non può essere riprodotto, salvo espressa autorizzazione. Gli autori sono responsabili delle opinioni espresse negli articoli e delle relative bibliografie.
abbonamenti
1 anno / 6 numeri
Italia Euro 43,00
Estero Euro 95,00
Per info e abbonamenti: abbonamenti@ecod.it
Inviare i dati completi per il recapito della rivista a abbonamenti@ecod.it prima di effettuare il pagamento. L’abbonamento può essere sottoscritto in qualsiasi giorno dell’anno e vale per i 6 numeri successivi.
stampa: Eurgraf sas
Autorizzazione alla pubblicazione - Tribunale di Milano n. 536 del 19/07/2004. Poste italiane spa - sped. in A. P.- D.L. 353/2003 (conv. in L. 27/02/2004 n. 46) art. 1, comma 1, DCB Varese
Vi informiamo che siamo in possesso dei vostri dati aziendali “non sensibili” e che questi vengono trattati nel pieno rispetto della Legge 675/96 attraverso l’utilizzo di supporti informatici e cartacei, con osservanza di ogni misura cautelativa della sicurezza e riservatezza dei dati, per la creazione e gestione di una mailing list da utilizzare per ciò che riguarda strettamente l’invio della rivista. Per esercitare i diritti previsti dalla Legge n. 675/96, gli interessati potranno rivolgersi al responsabile trattamento dati Luca Codato presso sede S. Vittore Olona.


LA PAROLA ALL’ESPERTO: Quale futuro è ipotizzabile per i prodotti della salumeria tradizionale?

20 DISTRIBUZIONE E CONSUMATORI: Il comportamento del consumatore nell’acquisto della carne - L’influenza dell’etichetta e del packaging

DOSSIER SURGELATI: Prodotti surgelati: trend in crescita anche per le specialità a base di carne
DOSSIER SURGELATI - LEGISLAZIONE: Alimenti surgelati e congelati - Quali differenze emergono dal quadro normativo di riferimento? 38 AZIENDE E INFORMATICA: M-ERP CSB-System - Mobilità, flessibilità e semplificazione dei processi industriali
Ecod Srl Unipersonale
Sede Legale: V.le Rimembranze 6 - 20020 Lainate MI
Redazione - Abbonamenti - Pubblicità: Via Don Riva 38 - 20028 San Vittore Olona MI Tel. 0331 518056 - Fax 0331 424780 - info@ecod.it www.ecod.it



EVENTI E RIFLESSIONI: Carne coltivata vs allevamento tradizionale. Una questione controversa, un dibattito necessario





Fervono i preparativi per la nona edizione di iMEAT, la fiera professionale organizzata da noi di ECOD Srl che, con passione, da più di dieci anni, pensiamo, organizziamo, allestiamo e guidiamo per dare al settore carne un impulso sempre più moderno, propositivo, innovativo e rivolto al futuro.
In questi anni molte cose sono cambiate, nella società, nel modo di concepire il mestiere, nel progresso della tecnologia ad esso applicata. Sono cambiati abitudini alimentari e obiettivi, per motivi che possiamo ricondurre alle profonde e rapide trasformazioni che il mondo intero sta attraversando e che sono dovute ad eventi estranei alla volontà dei più, e che influenzano le economie e gli equilibri globali impattando su tutti.
A questi cambiamenti abbiamo cercato di rispondere con sempre maggiore impegno per intercettare, mitigare o amplificare le esigenze e le richieste specifiche degli operatori del settore.
Per il 2025 abbiamo previsto di valorizzare ulteriormente il padiglione dedicato alle tecnologie ampliando la proposta di macchine e prodotti per la lavorazione e la conservazione di carni e salumi
LE AREE TEMATICHE DI iMEAT
• TEC - Area dedicata all’esposizione di tecnologie, attrezzature, aromi e ingredienti per la lavorazione, la conservazione e la cottura della carne e dei salumi.
• FOOD - Area con prodotti alimentari di eccellenza.
• GRILL - Area riservata a tecnologie, attrezzature, tendenze e metodi professionali di cottura delle carni.
Novità 2025, Passione Fuoco - Sarà allestito, attiguo all’area GRILL, un padiglione dedicato alle dimostrazioni di cottura grill con fiamma libera. Nell’area esterna verranno inoltre esposte le nuove tendenze di cottura bbq.
iMEAT CAMBIA LOOK
E per offrire a tutti l’immagine di questo slancio all’innovazione, il logo iMEAT e la grafica cambiano look, diventano più moderni e lineari, con un impatto che vuole facilitare la lettura e l’individuazione dei contenuti.
Abbiamo intensificato la comunicazione social – strumento indispensabile nel mondo moderno – e sui nostri canali facebook, instagram, youtube ci piace condividere le esperienze “carnivore” per rendere tutti partecipi e stimolare il dibattito, sempre moderato, come si conviene.
Siamo – desideriamo essere – lo specchio del mondo carne, che è anche il nostro. Lavoriamo insieme per costruire su basi solide un futuro degno e fruttuoso.
…e vi aspettiamo a iMEAT dal 23 al 25 MARZO 2025 a ModenaFiere.
Scopri tutte le opportunità che ti aspettano a iMEAT 2025: contatta la segreteria organizzativa ECOD Srl per ricevere maggiori informazioni.
www.imeat.it
Tel. +39 0331518056
PER ESPORRE: office@imeat.it PER VISITARE: info@imeat.it
TECNOLOGIE, ATTREZZATURE, AROMI, INGREDIENTI per lavorazione, conservazione e cottura di carne e salumi
ECCELLENZE ALIMENTARI per dettaglio e HoReCa
TECNOLOGIE, ATTREZZATURE, TENDENZE, METODI di cottura grill professionale
Provisur è azienda leader nella produzione di attrezzature per la lavorazione industriale degli alimenti con sede centrale a Chicago, Illinois, con numerose filiali in Europa.
Tra le macchine per separazione presentate in anteprima mondiale ad Anuga Food Tec 2024 c’era anche il Bone Cannon ridisegnato.
Le ossa rappresentano una risorsa preziosa della carne anche dopo il taglio e il Bone Cannon separa la carne dalle ossa, consentendo ai produttori di ottenere il massimo ritorno di investimento possibile dalla materia prima. Il nuovo design offre un recupero della carne ancora più elevato, evitando di sprecare proteine preziose tra gli scarti e consentendo di utilizzarle al minimo costo per applicazioni come polpette di carne, salsicce e altro. Inoltre, il nuovo design riduce il consumo d’acqua al minimo assoluto, mentre il nuovo motore anche il consumo energetico e un considerevole abbassamento del livello di rumore. Oltre alla facilità d’uso e alla resa eccellente, il nuovo Bone Cannon® si distingue per l’igiene e la sostenibilità.
Insieme al Bone Cannon® l’azienda ha proposto anche il Soft Tissue Separator STS 2000 che consente una separazione efficiente di carne di manzo, maiale e pollame. Elimina tendini, cartilagini, frammenti di ossa e altro preservando l’integrità e la struttura degli alimenti; e il SME 1830, un’eccellente attrezzatura per recuperare la carne dalle ossa ed evitare di sprecare proteine preziose, ideale per MDM e MSM di manzo, maiale e pollame e per il recupero del materiale necessario per la produzione di salsicce e pepite, ma anche per pesce e frutta.

Si chiama ‘Smart Meat 2030 – Sustainable Management and Advanced Responsible Technologies for Meat Ecosystems and Agri-food Tracking – ed è stato firmato al Senato nel corso di un incontro indetto su iniziativa del senatore Antonio De Poli in collaborazione con la Fondazione per la Sostenibilità Digitale. La Fondazione, con il contributo scientifico del centro studi di Carni Sostenibili, ha realizzato un rapporto sullo stato dell’arte della digitalizzazione nel settore e sui benefici che potrebbe apportare riducendo i costi e guadagnando in efficienza. Il Manifesto è aperto ad associazioni, aziende e Istituzioni che vogliano collaborare nella costruzione di un sistema più avanzato, dalla valorizzazione della tecnologia e sostenibilità digitali alla necessità di infrastrutture, competenze e formazione; dalla costruzione di ecosistemi data driven, al monitoraggio delle emissioni e del benessere animale, passando dalla questione della sicurezza informatica, al ruolo strategico delle Istituzioni.
Organizzato in occasione di ogni edizione di SIAL Paris, SIAL Innovation è un concorso che premia le migliori innovazioni alimentari a livello mondiale. Contraddistingue le aziende attraverso 3 premi (Oro, Argento e Bronzo) e una ventina di premi per settore e premi speciali.
Sial Innovation è una vetrina per il futuro dell’alimentazione, con circa 2500 nuovi prodotti presentati ad ogni edizione, che rappresentano circa il 10% dell’innovazione mondiale in materia di prodotti alimentari. Nel 2024 verranno assegnati 4 nuovi premi:
• premio 60 anni: per la migliore innovazione storica
• premio per i primi 3 Paesi che hanno offerto i prodotti più innovativi
• premio Africa, incentivato sulle iniziative africane
• premio per il concetto, per l’azienda/idea con un’idea o potenzialità del processo/innovazione in via di sviluppo.
Le candidature potranno essere presentate fino al 30 agosto 2024.
Lactalis Italia annuncia un piano di sviluppo che prevede la creazione in Italia di un nuovo team dedicato al benessere animale e la sostenibilità in stalla, per una filiera del latte sempre più sostenibile.
La visione di sostenibilità di Lactalis è incentrata sui tre pillar strategici: benessere animale, packaging circolare e riduzione di emissioni lungo tutta la filiera: il Gruppo dà il via ad un ciclo di incontri formativi e informativi rivolti agli allevatori al fine di mantenere un dialogo sempre aperto e trasparente.
Al centro del lavoro del team dedicato alla CSR in stalla, i pilastri dell’impegno di Lactalis:
- SOSTENIBILITÀ E RIDUZIONE EMISSIONI - il Gruppo sta accelerando la transizione verso modelli di riduzione delle emissioni di carbonio con l’obiettivo del - 25% e -50% di emissioni di gas serra di scope 1 e 2 rispettivamente entro il 2025 e 2033 e il raggiungimento del carbon net-zero entro il 2050.
- BENESSERE ANIMALE - Lactalis collabora con i propri conferenti latte affinché applichino i più alti standard di Animal Welfare. Oggi il 100% dei conferenti latte è conforme al sistema ClassyFarm, che garantisce una corretta conduzione dell’allevamento per animali sani e ben accuditi. L’impegno nei confronti del benessere animale riflette l’attenzione di Lactalis alla qualità e all’etica nella produzione dei propri prodotti lattiero-caseari.











• Nuova tecnologia all-in-one: disidratazione, cottura e arrostitura al forno a convezione forzata
• Grande versatilità: Possibilità di essiccare, cuocere e arrostire al forno tutti i tipi di prodotti e formati
• Accelerazione dell’innovazione: favorisce lo sviluppo di nuovi prodotti Ready-to-Eat
• Sviluppo di nuovi prodotti: proteine alternative e prodotti di carne alternativi
• Ottimizzazione dei processi: Prestazioni più elevate e consumi molto ridotti
• Connettività totale 4.0: Pieno controllo del processo automatico



RICCARDO CAVANNA CONFERMATO
PRESIDENTE
Riccardo Cavanna è stato confermato come Presidente di Ucima (Associazione Costruttori Italiani Macchine Automatiche per il Confezionamento e l’Imballaggio) per il biennio 2024-2026. Lo ha sancito all’unanimità l’annuale Assemblea Generale dei Soci, svoltasi a Baggiovara di Modena, presso la sede dell’Associazione a Villa Marchetti. Cavanna potrà così dare continuità all’intenso lavoro svolto negli ultimi due anni, andando così a completare un quadriennio. I Soci hanno eletto anche i nuovi vicepresidenti: si tratta di Massimo Marchesini (confermato) e di Antonella Candiotto.
Il Ministero della Salute ha finanziato il progetto ASFree M.e.a.t - African Swine Fever free M.e.a.t. (Meet export agreement on trading).
Il progetto è coordinato dall’Istituto zooprofilattico sperimentale dell’Umbria e delle Marche, sede del Centro di referenza nazionale Pesti suine (Cerep), e ha come partner l’Istituto zooprofilattico sperimentale della Lombardia e dell’Emilia Romagna; l’Istituto zooprofilattico sperimentale delle Venezie e l’Istituto zooprofilattico sperimentale dell’Abruzzo e del Molise. Il progetto punta a:
• generare dati aggiornati sulla presenza del virus della peste suina africana (Psa) nei prodotti a base di carne stagionati;
• valutare l’efficacia dell’applicazione del trattamento ad alta pressione (HPP) per la totale devitalizzazione del virus.
Il trattamento HPP, anche definito “pascalizzazione”, è una tecnica di conservazione non termica che si applica ad alimenti solidi e liquidi già confezionati, quindi non passibili di successiva contaminazione. La tecnologia è basata sull’applicazione di pressioni idrostatiche nettamente superiori a quella atmosferica (fino a 6.000 bar) che consentono di raggiungere l’inattivazione dei microrganismi presenti e rendere i prodotti alimentari stabili, conservabili e sicuri.
Perché le nostre scelte a tavola sono centrali per noi e per il mondo in cui viviamo? Perché nella nostra dieta le proteine sono fondamentali, e perché la dieta mediterranea è il modello alimentare ideale per assumerle? A queste domande risponde la Fondazione Istituto Danone con il volume Proteine nella dieta mediterranea, a cura di Federico Mereta, edito da Gribaudo e realizzato da un board scientifico di esperti (i Professori Lorenzo Morelli, Andrea Ghiselli, Maurizio Muscaritoli e Michele Sculati, la Professoressa Elisabetta Bernardi e l’Ingegnere Assunta Filareto).
La dieta mediterranea è un modello alimentare vario ed equilibrato in termini di quantità e densità energetica degli alimenti. Le proteine hanno una funzione plastica fondamentale: costruiscono, riparano, mantengono il benessere di cellule e tessuti che, anche e proprio grazie a loro, sono costantemente rimpiazzati.
Esiste una connessione certa tra il consumo di proteine e la salute e, specificamente, tra il consumo di proteine e la sopravvivenza complessiva. Ci sono evidenze scientifiche che dimostrano che l’aumento dell’assunzione di proteine può essere inversamente associato alla mortalità. Le Linee Guida per una corretta alimentazione in Italia raccomandano un consumo equilibrato di proteine animali e vegetali: nell’ambito di un sano stile di vita, l’introito proteico ideale dovrebbe derivare per il 45% dalle proteine animali e per il 55% dalle proteine vegetali.

Proteine nella dieta mediterranea è un libro pensato per il benessere di tutti, senza rinunciare ai gusti della tradizione, straordinariamente varia e completa, e per contribuire a diffondere nel dibattito sull’alimentazione messaggi fondati sul rigore della scienza.
La cucina italiana, candidata all’Unesco, si conferma ambasciatrice di eccellenza del made in Italy alla 68a edizione del Summer Fancy Food a New York, la più grande manifestazione fieristica del Nord America e una delle principali al mondo dedicate al settore specialty food e bevande.
In questa occasione, Matteo Zoppas, presidente ICE ha confermato che gli Stati Uniti restano uno dei principali mercati strategici per lo sviluppo dell’internazionalizzazione del made in Italy.
L’Italia è stata rappresentata in un’area espositiva di 2.800 mq con circa 290 espositori.

CULTURE MICROBICHE “MADE IN ITALY”
CULTURE MICROBICHE “MADE IN ITALY” PER LA VALORIZZAZIONE DELLA BIODIVERSITÀ
Bioagro
Bioagro

Rovagnati annuncia la collaborazione con PizzAut per il lancio del nuovo progetto PizzAutoBus, una flotta di 12 Food Truck che viaggeranno in Lombardia e in tutta Italia moltiplicando le occasioni di inclusione lavorativa. Rovagnati ha contribuito donando all’associazione un truck attrezzato per la preparazione e la distribuzione di pizze in provincia di Monza e Brianza, che andrà a formare e incrementare la flotta. Ogni mezzo, che potrà impiegare fino a cinque persone autistiche, sarà in seguito affidato a realtà associative e onlus che si occupano di autismo: una catena di lavoro che ha l’obiettivo di contribuire in maniera concreta alla creazione di nuovi posti di lavoro in tutto il Paese, in ottica di inclusività.
Nell’ambito della collaborazione, PizzAut includerà all’interno del menù proposto da tutti i Food Truck una pizza speciale al Gran Biscotto, prodotto di punta dell’azienda, che si distingue per l’alta qualità e il sapore unico.

Secondo mandato consecutivo per Alessandro Utini alla presidenza del Consorzio del prosciutto di Parma. Dopo aver guidato il Consorzio negli ultimi tre anni e con una lunga esperienza istituzionale all’interno dell’ente, di cui già fu Presidente dal 2004 al 2005, oltre ad aver ricoperto il ruolo di Vice-Presidente ed essere stato per oltre 20 anni consigliere di amministrazione, Utini è a capo di un comparto che vale 850 milioni di euro alla produzione e 1,7 miliardi al consu-
mo e impiega circa 3.000 addetti alla lavorazione del prodotto nella provincia di Parma. 130 sono le aziende associate e 7 milioni e mezzo i Prosciutti di Parma marchiati nel 2023. L’imponente filiera produttiva in cui il comparto è inserito comprende 3.600 allevamenti suinicoli e 78 macelli mentre 50.000 sono le persone impiegate nell’intero circuito tutelato. Lo affiancheranno in questo mandato la Vice-Presidente vicaria Gaia Baiocchi e la Vice-Presidente Giorgia Capanna.
Una ricerca di mercato condotta nei primi mesi di commercializzazione della nuova linea di salumi high protein firmata Coati ha evidenziato che l’indice di gradimento dei consumatori è molto elevato: il 71% degli intervistati apprezza soprattutto “l’elevato contenuto di proteine nobili”, mentre il 66% trova interessante anche “il basso apporto di grassi”. Particolarmente accattivante risulta “il formato pratico e maneggevole da 80 grammi”, così come il packaging ritenuto efficace e completo.
In una confezione di Fette Pro sono contenuti ben 16 grammi di proteine e un basso apporto di grassi (1,6 grammi): le proteine sono indispensabili in particolare per chi fa sport, poiché favoriscono la crescita muscolare e migliorano il funzionamento metabolico.
Non è un caso che di recente si assista a un vero e proprio boom di vendita dei prodotti proteici.
Prosciutto cotto, pollo e tacchino al forno - ad alto contenuto di proteine nobili, con pochi grassi e tanto gusto - sono proposti in un formato da 80 grammi, pratico e maneggevole.


Sono numerose le novità di Citterio presentate al Cibus: dedicate al territorio toscano, ecco il nuovo Prosciutto Toscano DOP, affettato in vaschetta preformata da 90 g; il Salame Toscano, caratterizzato da una consistenza compatta e dal colore rosso scuro, dal gusto aromatico dato dal caratteristico mix di spezie; il Salame al Finocchio, dal profilo aromatico distintivo, grazie anche ai semi di finocchio che regalano un tocco fresco e aromatico, e infine il Prosciutto Cotto Arrosto, una ricetta originale grazie al mix di spezie ed erbe aromatiche che unita alla lunga e lenta cottura conferiscono al prodotto una particolare morbidezza e un sapore avvolgente ed aromatico.
L’altra novità presentata da Citterio sono le Tagliette di guanciale, pancetta affumicata e pancetta dolce. L’azienda ha puntato su una nuova forma diversa e più spessa che valorizza la realizzazione delle ricette in chiave gourmet. Il nuovo taglio al coltello è stato studiato per esaltare la bontà di ogni piatto e ricorda quanto viene fatto a partire dal pezzo intero sia a casa che nelle cucine dei ristoranti. Nel formato da 90 grammi, in mono vaschetta per evitare sprechi, le Tagliette di guanciale hanno un sapore unico e avvolgente, quelle di pancetta affumicata un sapore deciso ma equilibrato, dato dall’affumicatura naturale con legno di faggio, mentre la pancetta dolce regala un gusto gentile e delicato.

La Farnesina comunica che il governo degli Stati Uniti ha riconosciuto l’Umbria e la Toscana come aree libere dalla malattia vescicolare del suino (MVS), con decorrenza dal 12 luglio. Questa decisione consentirà la riapertu-

Parmacotto Group rafforza il proprio impegno per la sostenibilità attraverso un progetto mirato alla gestione responsabile degli alimenti, un'iniziativa finalizzata non solo alla riduzione degli sprechi, ma anche alla promozione di pratiche eco-friendly lungo tutta la catena di produzione e distribuzione. In quest'ottica, la partnership tra Parmacotto Group e Regusto - ecosistema circolare italiano della sostenibilità che si basa su un modello di
ra delle esportazioni di prodotti di carne suina freschi e a breve stagionatura da Toscana e Umbria verso gli Stati Uniti. Consentito dunque l’export in USA di prodotti come Cinta Senese DOP, Finocchiona IGP Lardo di Colonnata IGP o Prosciutto di Norcia IGP.
Il Made in Italy dei salumi esportati negli USA si arricchirà quindi dei prodotti a “bassa stagionatura” elaborati in Toscana che andranno ad affiancare quelli già autorizzati a “lunga stagionatura” per la stessa regione, e di tutti i prodotti di salumeria della Regione Umbria. Si tratta di un grande ampliamento di gamma di prodotti che consentirà alle aziende toscane e umbre, che potranno strutturarsi in accordo alla normativa per l’export oltreoceano, di allargare il proprio mercato con quello degli Stati Uniti d’America a partire dalla data di riconoscimento ufficiale del 12 luglio 2024.

sharing for charity innovativo che sfrutta la tecnologia blockchain per garantire trasparenza e tracciabilità nella gestione dei flussi di denaro e merci - si configura come un chiaro segnale del profondo impegno del Gruppo nell'abbracciare i principi di responsabilità ambientale e sociale. L'obiettivo del progetto è implementare soluzioni concrete per prevenire e ridurre lo spreco alimentare, ma anche promuovere attivamente l'economia circolare, ponendo così le basi per un futuro più sostenibile e consapevole. Attraverso questa piattaforma, Parmacotto potrà donare le proprie eccedenze alimentari digitalizzando e tracciando i flussi in maniera trasparente.

Giuseppe L. Pastori - Tecnologo Alimentare
Nonostante l’aumento della quota di mercato delle proteine alternative, è difficile pensare una regressione dei prodotti di salumeria tradizionale. Tra l’altro questi potranno beneficiare di nuove tecnologie e dell’intelligenza artificiale per migliorare efficienza e ridurre i consumi energetici, mentre di sicuro aumenteranno le richieste di prodotti salutari e sostenibili. Con un’incognita per i prodotti ad indicazione d’origine legati al territorio: fino che punto i cambiamenti climatici influiranno sulla qualità e la disponibilità delle materie prime?
Forse nessuno, nemmeno Nostradamus, ha mai vaticinato qualcosa sul futuro delle produzioni alimentari, tanto meno ha parlato in senso più stretto di quale indirizzo seguirà l’industria delle carni. Quale futuro potremmo ipotizzare senza incorrere nell’azzardo di fare affermazioni un po’ forzate e poco chiare? Abbiamo una serie di fatti che ci possono aiutare a delineare un quadro prospettico sulle tendenze dell’innovazione tecnologica, compreso il ricorso all’intelligenza artificiale che potrà migliorare anche gli aspetti legati alla gestione della produzione e del post produzione, aiutando a ridurre gli sprechi alimentari. Come variabili incidentali vanno considerati i problemi derivati dal mutamento climatico che potrebbero influire sulla qualità e sulla disponibilità di alcune carni legate al territorio. Inoltre continuerà a sussistere la richiesta di prodotti maggiormente sostenibili, sicuramente più orientati all’impiego di prodotti naturali e biologici. Occorre considerare del resto che alcune delle tendenze che si vanno delineando sono in qualche modo volte al raggiungimento degli Obiettivi di Sviluppo sostenibile dell’Agenda ONU 2030 (SDGs)1, nonché a
quelli del Green Deal europeo focalizzati sul sostegno alla transizione della sostenibilità, come dimostrano con sempre maggior attenzione anche i consumatori.
La produzione salumiera è fatta di prodotti maturi legati alla tradizione, molto apprezzati in ambito alimentare e che per questo aspetto potrebbero continuare ad essere richiesti per via della loro qualità e autenticità. Molte di queste specialità, soprattutto nel panorama italiano, derivano da prodotti a denomi-
1Soprattutto quelli riguardanti l’utilizzo di forme di energia a basso impatto (SDG 7), l’innovazione e le infrastrutture perché siano resilienti, responsabili e sostenibili (SDG 9), l’attenzione a modelli di consumo responsabili con impatto sulla supply chain (SDG 12), la promozione di azioni atte a combattere il cambiamento climatico (SDG 13).
nazione d’origine che rispondono a precisi disciplinari di produzione. E questi, pur adeguandosi alle nuove tecnologie rimangono sostanzialmente immutati nella forma, nella presentazione e nel profilo sensoriale che li caratterizzano e che d’altra parte, come consumatori, ci attendiamo per ogni tipo di prodotto che conosciamo e consumiamo. È difficile oggi pensare al lancio di nuovi prodotti di salumeria in fatto di forma e di formulazione (non semplicemente un restyling come avviene per altre tipologie di manufatti o un diverso tipo di presentazione ma senza cambiare la loro natura), nemmeno ipotizzando l’impiego di specie animali meno comuni come pecora, cervo, struzzo o carni esotiche autorizzate come magari quella di coccodrillo o di canguro. In effetti ciò trova il tempo che trova: la produzione con carni alternative è una nicchia per via delle quantità limitate e non modifica nulla rispetto a ciò che siamo abituati a consumare perché otterremo sempre prodotti in forma di sala-

me crudo o altro insaccato cotto oppure a pezzo intero modellato e stagionato, affumicato e/o cotto.
Quello che si può ipotizzare e in parte cercheremo di analizzare, riguarda soprattutto la prospettiva di aumentare il livello di servizio delle produzioni esistenti che, applicando nuove tecnologie e l’intelligenza artificiale, portano al miglioramento della tracciabilità e della sicurezza, ovvero favoriscono la transizione verso modelli più sostenibili [1]. Ad esempio, con un approccio alla blockchain, le aziende possono monitorare e registrare tutta la catena di produzione, dall’allevamento alla trasformazione fino al confezionamento, garantendo la massima sicurezza e qualità. Con un maggiore ricorso alla digitalizzazione si può giocare un importante ruolo nello sviluppo dei prodotti tradizionali, orientandoli alla vendita online (più di quanto si faccia ora) o alla promozione sui social media. Pensando a introdurre packaging più sostenibili per l’ambiente, utilizzando di più carta, cartone e fibre di cellulosa per le confezioni a libero servizio, che si possono anche fustellare, si riduce l’impiego di plastica e si favorisce il riciclo in un’ottica di economia circolare. Infine, con il ricorso all’impiego di fonti energetiche naturali e alla cogenerazione, oltre a motivare l’azienda ad essere più sostenibile e meno dipendente da fonti fossili (che può diventare un veicolo per migliorare ulteriormente l’immagine societaria), si possono sostituire i processi convenzionali ad alta intensità energetica con quelli a minor impatto ambientale, offrendo il potenziale per ridurre il consumo di energia e i costi di produzione, senza particolari cambiamenti infrastrutturali.
ESEMPI DI TECNOLOGIE
EMERGENTI PER LA
LAVORAZIONE DELLA CARNE
Tra le applicazioni emergenti che si possono utilizzare in sostituzione dei processi convenzionali altamente energivori, si possono annoverare le alte pressioni (HPP), il riscaldamento ohmico (OH), i campi elettrici pulsati
Con un approccio alla blockchain, le aziende possono monitorare e registrare tutta la catena di produzione, dall’allevamento alla trasformazione fino al confezionamento, garantendo la massima sicurezza e qualità
(PEF), le radiofrequenze e gli ultrasuoni (US). Sono tecnologie a dire il vero che esistono già ma per la lavorazione delle carni alcune di queste applicazioni hanno bisogno ancora di studi per ottimizzare le condizioni di lavoro e passare da una piccola scala di laboratorio a un ambito industriale. Molte di queste applicazioni utilizzano maggiormente il campo elettrico come fonte di alimentazione primaria e quindi possono sfruttare la generazione di corrente fornita da fonti rinnovabili o da cogenerazione impiegando anche diversi tipi di biomasse, compreso il biogas. Analizziamole qui di seguito nel dettaglio.
Le alte pressioni (HPP) sono utilizzate oggi come forma di pastorizzazione a freddo applicata ai prodotti confezionati top di gamma per garantire la sicurezza e la stabilità, incrementando la durata di conservazione. Poiché le onde d’urto generate dalle alte
pressioni rompono le membrane cellulari dei microrganismi (ma non le fibre muscolari), c’è la certezza che tutte le forme di microrganismi patogeni, compresa la Listeria monocytogenes, vengano completamente uccise [2]. E dal momento che questa tecnologia può garantire Listeria pari a zero, è un’applicazione riconosciuta anche in USA come processo ideale per la sanificazione e la salubrità degli alimenti. Il limite del suo impiego è principalmente dovuto al fatto che il processo è necessariamente basato sul concetto di lotto, non potendo ipotizzare il mantenimento delle alte pressioni in un circuito aperto e continuo. Un altro limite è il fatto che è necessario utilizzare un packaging flessibile plastico: pertanto confezioni che impiegano come base strutturale carta e cartone non possono essere utilizzate perché si imbibirebbero dell’acqua in cui sono immerse, deteriorandosi.
2. RISCALDAMENTO OHMICO
Il riscaldamento ohmico (OH) è una tecnologia emergente utilizzata per riscaldare gli alimenti tramite il passaggio di corrente elettrica attraverso di essi. È particolarmente adatta per la lavorazione delle carni [3], in quanto la corrente elettrica riesce a penetrare in profondità nel prodotto garantendo un riscaldamento uniforme e controllato, mantenendo intatte le proprietà organolettiche dell’alimento. Può essere utilizzata per diverse applicazioni, come ad esempio la pastorizzazione, la sterilizzazione e la cottura. Migliora la texture della carne, rendendola più morbida e succulenta. Questo è particolarmente utile per la produzione di prosciutti e insaccati, che richiedono una lavorazione precisa e delicata per garantire la qualità finale. In generale, tra i vantaggi offerti si possono considerare una maggiore efficien-

za energetica, una maggiore precisione nel controllo della temperatura e dei tempi di cottura, una migliore conservazione delle proprietà organolettiche del prodotto e una maggiore omogeneità nella lavorazione. Tuttavia, è importante tenere presente che l’uso del riscaldamento ohmico richiede attrezzature specializzate e una corretta gestione del processo per garantire la sicurezza alimentare e la qualità del prodotto finale.
ELETTRICO
La tecnologia del campo elettrico pulsato (PEF) si basa sull’applicazione di impulsi elettrici di breve durata e di elevata intensità su un alimento preferibilmente liquido o semisolido [4]. Questi impulsi generano un campo elettrico che provoca un aumento temporaneo della permeabilità delle membrane cellulari presenti negli alimenti, garantendo un effetto pastorizzante non termico in grado di inattivare, portandoli a morte, i microrganismi presenti: quando le membrane vengono danneggiate, le cellule microbiche perdono la loro integrità strutturale e funzionale. Il trattamento assicura pertanto una riduzione significativa dei microrganismi patogeni o deterioranti, garantendo la conservazione delle proprietà sensoriali, nutrizionali e organolettiche dei prodotti. La tecnologia PEF è ancora allo stadio di sperimentazione e studio, ma se ne stanno esplorando le potenzialità per migliorare la qualità e l’efficienza nella produzione dei salumi.
Le prospettive future prevedono un maggiore utilizzo di tecnologie come l’intelligenza artificiale, la tecnologia blockchain e l’automazione dei processi

Una tecnologia già in uso (anche se richiede ovviamente impianti specifici) sono le radiofrequenze, ovvero onde elettromagnetiche che vengono emesse a diverse lunghezze d’onda (in campo alimentare, si situano tipicamente nell’intervallo di frequenza compreso tra i 10 megahertz MHz e i 6 gigahertz GHz), che possono essere utilizzate per diverse applicazioni [5]. Nel settore della salumeria possono essere impiegate per lo scongelamento delle carni, per il riscaldamento e il taglio dei grassi, nel processo di cottura e nel monitoraggio delle condizioni ambientali durante la stagionatura (temperatura e umidità). Nello scongelamento con radiofrequenze, le onde elettromagnetiche

riscaldano le molecole d’acqua presenti nel prodotto, facendo aumentare la temperatura e accelerando il processo. Questo metodo consente di ottenere uno scongelamento più uniforme e controllato, riducendo al minimo il rischio di perdita di qualità o di proliferazione batterica.
Infine abbiamo gli ultrasuoni (US), già impiegati in campo analitico e in modo non invasivo nell’ambito della produzione della carne per misurare il grasso corporeo e per determinare le proprietà fisiche degli alimenti (viscosità, densità e consistenza). Uno dei principali utilizzi di tale tecnologia nel settore delle carni è il taglio ultrasonico. Questo metodo consente di tagliare le carni in modo preciso e uniforme, riducendo al minimo lo spreco di materiale. Inoltre, permette di ottenere carne con una migliore presentazione e consistenza. Gli ultrasuoni vengono anche impiegati per rendere più tenere le carni [6]: attraverso il processo di sonificazione, vengono infatti rotte le fibre muscolari dell’alimento, rendendolo più morbido e succulento. Questo risultato viene raggiunto in un periodo più breve rispetto alla frollatura naturale, un processo che è necessario per tutte le carni dopo la macellazione e prima del consumo, soprattutto per quelle bovine.
Le strategie di produzione e i sistemi di lavorazione della carne stanno subendo importanti cambiamenti per rispondere alle esigenze dei consumatori moderni che oggi
È importante che i produttori e le industrie agroalimentari adottino misure di adattamento e mitigazione per far fronte alle variazioni climatiche e garantire la continuità della produzione di alimenti legati al territorio
sono più istruiti e informati rispetto al passato, sempre più attenti alla qualità e alla sostenibilità di ciò che acquistano. La richiesta di alimenti più sicuri, nutrienti, rispettosi del benessere animale e che offrono maggiori benefici per la salute, spinge verso l’utilizzo di ingredienti naturali, di matrice biologica e sostenibile.
Allo stesso tempo anche l’industria della carne deve affrontare sfide importanti legate alla sicurezza alimentare (in un contesto di globalizzazione), alla tracciabilità della filiera produttiva, alla riduzione degli sprechi, all’utilizzo di impianti di riciclaggio degli scarti e a implementare pratiche di produzione più attente alla tutela ambientale. Riguardo quest’ultimo aspetto si deve conciliare l’aumento della domanda di alimenti ad alto valore nutrizionale (come la carne e i prodotti a base di carne) per ridurre la povertà e la fame di una popolazione mondiale in crescita, con la necessità di un’azione di salvaguardia del clima: occorre comprendere e mettere in atto dei compromessi per raggiungere questi obiettivi su scala globale, per una transizione verso una produzione di carne (soprattutto bovina) più sostenibile [7]. In questo senso, avere un approccio positivo verso potenziali strumenti innovativi potrebbe creare i presupposti per raggiungere entrambi gli obiettivi.
Le prospettive future prevedono un maggiore utilizzo di tecnologie come l’intelligenza artificiale, la tecnologia blockchain e l’automazione dei processi. Ciò consentirà di migliorare l’efficienza e la trasparenza della filiera produttiva, garantendo inoltre una maggiore sicurezza alimentare e una minore impronta ambientale.
L’intelligenza artificiale può intervenire in diversi modi per migliorare le produzioni tradizionali della salumeria. Ecco alcuni esempi.
1. Ottimizzazione dei processi: l’IA può essere impiegata per analizzare i dati relativi ai processi di produzione e identificare eventuali inefficienze o aree di miglioramento. Attraverso l’analisi dei dati in tempo reale è possibile ottimizzare i flussi di produzione, ridurre gli sprechi e migliorare la qualità del prodotto finale.
2. Controllo qualità: l’IA può essere utilizzata per sviluppare sistemi di visione artificiale in grado di rilevare difetti o anomalie nei lotti di produzione, garantendo una maggiore precisione nel controllo qualità.
3. Predizione della domanda: utilizzando algoritmi di “machine learning”, è possibile analizzare i dati relativi allo storico delle vendite, alle tendenze di mercato e ai dati demografici per prevedere con maggiore precisione la domanda di prodotti di salumeria. Questo permetterà alle aziende di pianificare in modo più efficiente la produzione, riducendo gli sprechi e garantendo la disponibilità degli articoli richiesti.
4. Ottimizzazione della catena di approvvigionamento: l’IA può essere utilizzata per migliorare la gestione della catena di approvvigionamento, ottimizzando i processi di logistica, la movimentazione degli stock e la pianificazione della produzione. Ciò permetterebbe di ridurre i tempi di consegna e i costi, migliorando nello stesso tempo l’efficienza complessiva della produzione salumeria.
carne e vegetali, è possibile ridurre l’impatto ambientale complessivo della produzione.
2. Migliore gestione delle risorse: combinare proteine animali e vegetali consente di ottimizzare l’utilizzo delle risorse disponibili, riducendo gli sprechi e migliorando l’efficienza della produzione.
3. Risposta alla domanda dei consumatori: sempre più consumatori sono interessati a ridurre il consumo di carne e ad adottare una dieta più equilibrata e sostenibile. Offrire prodotti che combinano proteine di carne e vegetali consente di soddisfare le esigenze di un pubblico sempre più diversificato e consapevole dell’impatto ambientale delle proprie scelte alimentari.
Anche l’aggiunta alle carni di altri ingredienti come certi funghi commestibili può contribuire a migliorare la composizione chimica e le proprietà funzionali di promozione della salute, perché sono fonti importanti di proteine e aminoacidi, carboidrati, minerali e vitamine, arricchendole anche con l’apporto di componenti bioattivi [9].

NON SOLO CARNI
TRA GLI INGREDIENTI PRIMARI
La combinazione di proteine animali e vegetali (o di altra natura) nella stessa formulazione è una pratica che sta diventando sempre più diffusa nel settore alimentare, anche nella produzione di prodotti a base di carne. Questo approccio consente non solo di offrire una maggiore varietà di prodotti ai consumatori, ma anche di promuovere la sostenibilità della produzione.
In questo contesto, integrare proteine vegetali nella formulazione delle specialità a base di carne [8] ha diversi vantaggi:
1. Riduzione dell’impatto ambientale: la produzione di proteine vegetali richiede generalmente meno risorse ambientali rispetto a quella di proteine animali. Utilizzando una combinazione di proteine di
In sintesi, offrire al mercato prodotti che utilizzano sia proteine di carne che vegetali o derivate da funghi nella stessa formulazione può essere un’importante strategia per promuovere la sostenibilità della produzione alimentare. Questa pratica non solo consente di ridurre l’impatto ambientale della produzione, ma offre anche ai consumatori opzioni più salutari, etiche e rispettose dell’ambiente.
QUANTO POSSONO INFLUIRE LE VARIAZIONI CLIMATICHE NELLA PRODUZIONE DI ALIMENTI LEGATI AL TERRITORIO?
Infine non possiamo sottovalutare che le variazioni climatiche potranno avere un impatto significativo sulla produzione di alimenti legati al territorio, soprattutto nei casi di alimenti a base di carne e produzioni DOP.

Le variazioni climatiche possono influenzare la disponibilità di pascoli e foraggi per il bestiame, causando una diminuzione della quantità e qualità della carne prodotta. Inoltre, condizioni climatiche estreme come siccità, alluvioni o ondate di calore possono compromettere la salute degli animali, riducendo ulteriormente la disponibilità di carne.
Per quanto riguarda le produzioni DOP (Denominazione di Origine Protetta), le variazioni climatiche possono avere delle ripercussioni sulla qualità e sulle caratteristiche distintive del prodotto. Ad esempio, nel caso dei formaggi DOP, possono influire sulle condizioni di maturazione e sull’aroma, compromettendo la loro autenticità.
Le variazioni climatiche possono anche avere un impatto sulla disponibilità di materie prime e sulla logistica della produzione, causando ritardi nella consegna della merce e aumenti dei costi di produzione. Un caso emblematico si è già riscontrato in Andalusia (Spagna), dove la siccità ha colpito le querce che hanno prodotto meno ghiande di cui si nutrono i maiali iberici per “Pata negra bellota”: perciò per garantire la qualità delle carni gli allevatori hanno dovuto estendere l’area del pascolo per avere una sufficiente disponibilità di cibo per gli animali e soddisfare i requisiti dell’etichetta [10]. In generale, è importante che i produttori e le industrie agroalimentari adottino misure di adattamento e mitigazione per far fronte alle variazioni climatiche e garantire la continuità della produzione di alimenti legati al territorio. Queste misure possono includere l’adozione di pratiche agricole sostenibili, l’utilizzo di tecnologie innovative per monitorare e prevenire gli effetti del cambiamento climatico e la diversificazione delle fonti di approvvigionamento e produzione. Infine, è fondamentale sensibilizzare i consumatori sull’importanza di sostenere la produzione di alimenti locali e di qualità, per preservare la biodiversità e la tradizione culinaria del territorio.
CONCLUSIONI
Il futuro dei prodotti della salumeria tradizionale potrebbe variare a seconda delle tendenze del mercato e delle preferenze dei consumatori. Sicuramente continuerà ad esserci una maggiore richiesta di alimenti salutari e
sostenibili, che potrebbe influenzare la produzione e la commercializzazione dei salumi tradizionali. Le nuove tendenze di consumo potrebbero porre una maggiore attenzione alla provenienza delle carni ottenute da allevamenti che sostengono il benessere animale e all’uso di ingredienti naturali e biologici, che del resto la stessa Unione Europea promuove in termini di sostenibilità.
Ovviamente in parallelo continuerà anche l’offerta di alternative alla carne con prodotti analoghi a base vegetale, a base di micoproteine, microalghe o insetti come ingredienti, e arrivando anche ad introdurre prima o poi sui nostri mercati i prodotti ottenuti dalla coltivazione cellulare. Tuttavia alcune di queste nicchie, come i prodotti di finta carne a base vegetale, pur continuando a garantire business milionari, sembrano essere arrivate già alla saturazione delle loro potenzialità (considerando che in America già falliscono
diverse società e molte altre ridimensionano le proprie aspettative). E in questa prospettiva l’industria delle carni non ha particolari motivi di preoccupazione, salvo una quasi normale erosione di parte del mercato per i business emergenti, considerando che nel mondo i consumi di carne (e dei rispettivi prodotti trasformati) sono dati in aumento.
L’impiego di nuove tecnologie che sfruttano di più la corrente elettrica, potrebbe portare a una transizione energetica riducendo la dipendenza dal consumo di fonti fossili, garantendo una migliore efficienza e una riduzione del costi energetici. Da parte sua l’intelligenza artificiale potrebbe contribuire a migliorare ulteriormente i processi identificando le inefficienze e incrementando le performance degli impianti con l’obiettivo di rendere i flussi di produzione più snelli, riducendo gli sprechi e migliorando la qualità del prodotto finito. L’IA potrebbe intervenire anche per migliorare la gestione delle merci, la logistica e la rotazione dei prodotti al fine di ridurre l’incidenza dello spreco alimentare.
In definitiva, il futuro dei prodotti della salumeria tradizionale non presenta tinte fosche e potrebbe essere caratterizzato da una combinazione di tradizione, innovazione e sostenibilità, per rispondere alle esigenze di un mercato in continua evoluzione.
Gli autori sono responsabili delle opinioni espresse negli articoli e delle relative bibliografie
1. Echegaray N., Hassoun A., Jagtap S., Tetteh-Caesar M., Kumar M., Tomasevic I., Goksen G., Lorenzo J.M. (2022). Meat 4.0: Principles and Applications of Industry 4.0 Technologies in the Meat Industry. Appl. Sci., 12, 6986. https://doi.org/10.3390/app12146986
2. Bolumar T., Orlien V., Bak K.H., Aganovic K., Sikes A., Guyon C., Stübler A.S., de Lamballerie M., Hertel C., Brüggemann D.A. (2020). High-pressure processing (HPP) of meat products: Impact on quality and applications. In: Present and Future of High Pressure Processing –Editor(s): Barba F.J., Tonello-Samson C., Puértolas E., Lavilla M. – Elsevier, pages 221-244
3. Yildiz-Turp G., Sengun I.Y., Kendirci P., Icier F. (2013. Effect of ohmic treatment on quality characteristic of meat: a review. Meat Sci., 93(3):441-8
4. Tomasevic I., Heinz V., Djekic I., Terjung N. (2023). Pulsed electric fields and meat processing: latest updates, Italian Journal of Animal Science, 22:1,857-866, DOI: 10.1080/1828051X.2023.2206834
5. Barge P., Biglia A., Comba L., Ricauda Aimonino D., Tortia C., Gay P. (2020). Radio Frequency IDentification for Meat Supply-Chain Digitalisation. Sensors. 20. 4957. DOI: 10.3390/ s20174957
6. Caraveo-Suarez R.O., Garcia-Galicia I.A., Santellano-Estrada E., Carrillo-Lopez L.M., Huerta-Jimenez M., Vargas-Bello-Pérez E., Alarcon-Rojo A.D. (2021). High-Frequency Focused Ultrasound on Quality Traits of Bovine Triceps brachii Muscle. Foods 10(9):2074. https://doi.org/10.3390/foods10092074
7. Castonguay A.C., Polasky S., Holden M.H., Herrero M., Mason-D’Croz D., Godde C., Chang J., Gerber J., Witt G.B., Game E.T., Bryan B.A., Wintle B., Lee K., Bal P., McDonald-Madden E. (2023). Navigating sustainability trade-offs in global beef production. Nature Sustainability 6(3): 284-294
8. Ball J.J., Wyatt R.P., Lambert B.D., Smith H.R., Reyes T.M., Sawyer J.T. (2021). Influence of PlantBased Proteins on the Fresh and Cooked Characteristics of Ground Beef Patties. Foods 10(9):1971. https://doi.org/10.3390/foods10091971
9. Torres-Martínez B.d.M., Vargas-Sánchez R.D., Torrescano-Urrutia G.R., Esqueda M., Rodríguez-Carpena J.G., Fernández-López J., Perez-Alvarez J.A., Sánchez-Escalante A. (2022). Pleurotus Genus as a Potential Ingredient for Meat Products. Foods 11(6):779. https://doi.org/10.3390/foods11060779
10. Il Pata Negra in crisi per il clima: mancano le ghiande per i maiali. Talignani G., in rubrica “Green&Blue” – la Repubblica (31 gennaio 2023).
https://www.repubblica.it/green-and-blue/2023/01/31/news/crisi_clima_pata_negra_ jamon_iberico_prosciutto-385926227/ (Consultato online il 10 aprile 2024)












distribuzione e consumatori

L’INFLUENZA DELL’ETICHETTA E DEL PACKAGING
Angela Mucciolo, Dottore
A.
Attraverso un’analisi dettagliata delle direttive e dei regolamenti europei che governano l’etichettatura ambientale e nutrizionale, si mira ad evidenziare il ruolo cruciale delle etichette nel guidare i consumatori verso prodotti con un minor impatto sull’ambiente e una maggiore qualità nutrizionale
L’etichettatura alimentare svolge un ruolo fondamentale nell’orientare le scelte dei consumatori durante gli acquisti. Attraverso informazioni chiare e dettagliate, fornisce una panoramica del prodotto, compresa la sua origine, gli ingredienti, e, in modo evidente, gli allergeni e altre sostanze rilevanti come l’olio di palma o gli OGM. Questo contribu-
isce a garantire la sicurezza alimentare e a soddisfare le esigenze dei consumatori con diverse sensibilità. Inoltre, l’etichettatura può anche presentare “claims,” ossia dichiarazioni facoltative che mettono in evidenza particolari qualità nutrizionali o benefici per la salute di un prodotto. Recentemente, nuovi sistemi di etichettatura FOP, noti come “Front of Pack”, sono stati introdotti per semplificare ulteriormente la comprensione da parte dei

consumatori dei valori nutrizionali e dell’impatto ambientale dei prodotti alimentari. L’Eco Score, ad esempio, considera l’intero ciclo di vita di un prodotto, dalla produzione al trasporto e all’imballaggio, con l’obiettivo di fornire informazioni chiare sull’aspetto ambientale del prodotto. Nel frattempo, il Nutri Score si concentra sugli aspetti nutrizionali, offrendo ai consumatori una visione immediata della qualità nutrizionale dell’alimento. Dal 1° gennaio 2023, con l’introduzione dell’etichettatura ambientale, si mira a promuovere il passaggio da un’economia lineare a una circolare. Questo sistema è stato
L’etichettatura alimentare svolge un ruolo fondamentale nell’orientare le scelte dei consumatori durante gli acquisti e influenzare il comportamento delle persone affinché esse ne ottengano dei benefici può avvenire promuovendo comportamenti corretti
progettato per facilitare la raccolta, il riutilizzo, il recupero e il riciclaggio degli imballaggi. Inoltre, fornisce ai consumatori informazioni chiare sulle destinazioni finali degli imballaggi, incoraggiando una gestione più responsabile dei rifiuti e il consumo consapevole. In questo lavoro vogliamo esaminare l’importanza dell’etichettatura ambientale e nutrizionale nei prodotti di consumo e il loro impatto sulla promozione di scelte consapevoli e sostenibili da parte dei consumatori. Attraverso un’analisi dettagliata delle direttive e dei regolamenti europei che governano l’etichettatura ambientale e nutrizionale, con un focus specifico sul contesto italiano, si mira ad evidenziare il ruolo cruciale delle etichette nel guidare i consumatori verso prodotti con un minor impatto sull’ambiente e una maggiore qualità nutrizionale.
L’ETICHETTATURA COME MEZZO DI COMUNICAZIONE DIRETTA AI CONSUMATORI
L’etichettatura alimentare svolge un ruolo fondamentale nell’orientare le scelte dei consumatori durante gli acquisti. Influenzare il comportamento delle persone affinché esse ne ottengano dei benefici può avvenire promuovendo comportamenti corretti, come avviene sia relativamente alle tematiche ambientali (Chawla & Cushing, 2007; Schultz & Kaiser 2012; Zibarras & Coan 2015; Zelenski & Desrochers, 2021) così come per quelle relative alla salute (Robertson, 2008; Webb et al., 2010; While, 2015).
Una strada alternativa, che permette di raggiungere lo stesso obiettivo, è anche quella,

al contrario, di disincentivare quelli scorretti (Sichieri et al., 2009; Popkin et al., 2021). Volendo citare un esempio emblematico di disincentivo verso una cattiva abitudine, si può sicuramente fare riferimento a quella del fumo. I tentativi volti a scoraggiare il consumo di sigarette sono numerosi (Grummon et al., 2022; Chaloupka et al., 2019; Fallin et al., 2015), ma il più noto resta sicuramente quello relativo alle avvertenze apposte direttamente sui pacchetti di sigarette, che è riuscito a ridurre la vendita di tabacco in America

I dati riportati sulle confezioni degli alimenti sono un fattore che influenzano in modo significativo l’opinione dei consumatori sul prodotto
(Noar et al., 2016). Questo risultato è dovuto al fatto che permettono di ridurre le associazioni positive con il fumo (Strong et al., 2021). Alcuni studi hanno poi osservato come le avvertenze sulla salute hanno ridotto l’acquisto di bevande zuccherate (Grummon et al., 2019) e merendine (Clarke et al., 2020). Uno dei mezzi che permette questo passaggio diretto dell’informazione ai consumatori al momento dell’acquisto del prodotto, sono le confezioni di questi ultimi, rivelatesi uno strumento efficace già da tempo (Underwood & Klein, 2002). Il packaging del prodotto, a maggior ragione nei prodotti che si mangiano, svolge numerose funzioni, sia dal punto di vista tecnico, che informativo (Han, 2014).
La confezione è fondamentale per poter mantenere la qualità dei prodotti alimentari per la conservazione, il trasporto e l’uso finale (Kelsey, 1985). Impedisce infatti il deterioramento della qualità degli alimenti o delle bevande, dovuti a fattori esterni (Restuccia et al., 2010) e contribuisce all’efficienza della distribuzione, delle vendite e del consumo (Han, 2014).
L’altro ruolo rilevante è quello relativo alla funzione che svolge in ambito marketing (Han, 2014). Esso, infatti, è un’importante leva, che funge come identificatore e creato-
re della brand image (Wyrwa & Barska, 2017). Inoltre, il nuovo design del packaging ha contribuito a fornire migliori opportunità di informazione al cliente ed è ritenuto per questo un mezzo di comunicazione utilizzabile direttamente nel punto vendita (Underwood & Klein, 2002; Young, 2004). La funzione informativa e promozionale dell’imballaggio è un attributo del quale si deve tener conto quando quest’ultimo viene progettato. La corretta progettazione del packaging di un prodotto infatti è parte integrante di una strategia di marketing e può contribuire ad aumentare la competitività e l’interesse degli acquirenti (Bandara et al., 2016). La funzione comunicativa dell’imballaggio è solitamente identificata con l’estetica, l’attrattiva visiva e le illustrazioni su di esso.
Queste informazioni devono innanzitutto soddisfare le esigenze dei consumatori, attirare la loro attenzione e suscitare in loro il desiderio di acquistare un prodotto (Bandara et al., 2016). I dati riportati sulle confezioni degli alimenti sono un fattore che influenzano in modo significativo l’opinione dei consumatori sul prodotto (Wyrwa & Barska, 2017). In particolare, ad esplicitare questa funzione, è l’etichettatura (Ares et al., 2013). Se da un lato serve per adempiere ad alcune necessità legali (Przyrembel, 2004), dall’altro è uno strumento di informazione richiesto anche dai consumatori. Quando questi si trovano difatti in difficoltà a scegliere tra diverse opzioni di un determinato prodotto, possono utilizzare le specifiche contenute nelle etichette per prendere una decisione (Imm et al., 2012) riducendo le asimmetrie informative tra produttori e consumatori (Marchini et al., 2021, Liu et al., 2021). Esistono delle apposite eti-
chettature che hanno come obiettivo quello di incentivare acquisti sostenibili, ovvero le eco-label, o salutari, le health label. Possiamo definire le prime come simboli ideati per identificare e distinguere i prodotti che hanno un impatto ambientale e sociale favorevole (Darnall et al., 2018), creati per ridurre l’incertezza dei consumatori riguardo alla validità degli acquisti sostenibili (Atkinson & Rosenthal, 2014).
Esistono delle apposite etichettature che hanno come obiettivo quello di incentivare acquisti sostenibili, ovvero le eco-label, o salutari, le health label
Ancora possono essere definite come strumenti di marketing verde, poiché hanno lo scopo di comunicare in modo visivo ai consumatori le caratteristiche sostenibili dei prodotti, al fine di agevolare un processo decisionale consapevole e di stimolare la richiesta di prodotti ecologici (Potter et al., 2021; Eldesouky et al., 2020). Anche se non sono il fattore più importante di cui un consumatore tiene conto al momento dell’acquisto, la loro presenza si è dimostrata avere un impatto positivo sulla reputazione dell’azienda, la fiducia verso di essa, e l’acquisto dei prodotti (Grankvist & Biel, 2007; Potter et al., 2021). Per questo motivo, dato l’aumentare della sensibilità ambientale dei consumatori, sempre più produttori di beni di largo consumo utilizzano etichette di qualità ecologica sui loro prodotti (Van Loo et al., 2015; Donato & D’Aniello, 2021).
Le health label (l’etichetta sanitaria) invece,

quali ad esempio le etichette nutrizionali, possono essere definite come strumenti che permettono ai consumatori di potersi informare in modo semplice e comprensibile, relativamente al valore nutrizionale degli alimenti, con il fine ultimo di poter fare scelte, oltre che più sane, anche consapevoli (Hercberg et al., 2021). Come le eco-label, esse hanno un impatto positivo sui prodotti (Dubois, et al., 2021). Secondo Johansen et al. (2011), la percezione della salubrità, congiuntamente al prezzo e al gusto, sono importanti predittori delle scelte alimentari. Inoltre, hanno una conseguenza indiretta sulle produzioni delle aziende, che cercano di migliorare la composizione nutrizionale dei loro prodotti, per essere meglio posizionati nella scala salutare (analogo effetto, per le eco-label) (Hercberg et al., 2021).
Se queste etichette hanno avuto degli effetti positivi sui prodotti più salutari ed ecologici, non hanno comunque un impatto su quegli alimenti che sono peggio posizionati sotto tali punti di vista, o che non hanno tali etichette sulla propria confezione (Dubois et al., 2021).
Per disincentivare l’acquisto di alcuni prodotti, è più efficace inquadrarli in una cornice negativa (Khandpur et al., 2019, Carrero et al., 2021), piuttosto che attribuirne un punteggio basso in una positiva (Dubois et al., 2021). Tale compito può essere svolto dalle etichette di avvertenza “Warning Labels” (WL). Queste etichette vengono definite come “veicoli informativi evidenti che vengono attaccati a un prodotto, progettati come parte dell’imballaggio, o inclusi nei manuali di istruzione o nel materiale promozionale che riguardano i pericoli associati all’uso del prodotto” (Purmehdi et al., 2017). L’efficacia è dovuta alla maggiore capacità di catturare l’attenzione, ridurre la percezione di salubrità del prodotto e ridurne l’intenzione di acquisto (Khandpur et al., 2018 a; Khandpur et al., 2018 b).
Ad avvalorare il fatto che i messaggi negativi possano essere più efficaci nel ridurre il consumo, alcuni studi suggeriscono come un messaggio inquadrato in maniera negativa, sia più efficace rispetto ad uno inquadrato in maniera positiva, a causa di una bias (distorsione) di negatività che fa sì che gli individui siano più spaventati da una perdita piuttosto che un guadagno equivalente (Meyerowitz & Chaiken, 1987; Kahneman, 1979; Cheng et al., 2011). Le informazioni negative catturano inoltre, una maggiore attenzione (Baumeister et al., 2001) e per un tempo più prolungato (Grankvist et al., 2004). Queste teorie, ad
esempio, sono state confermate da alcuni studi in cui le avvertenze grafiche relative alle conseguenze negative del fumo, sono riuscite a ridurne il consumo (Brewer et al., 2016; Strahan et al., 2002).
Nel contesto della dissuasione del consumo di prodotti ultra-lavorati, le avvertenze nutrizionali possono contrastare la gratificazione immediata di questi prodotti, ricordando ai consumatori i maggiori rischi per la salute e la potenziale perdita della stessa, derivanti dal loro consumo eccessivo (Taillie et al., 2020).
L’introduzione dei pacchetti GWL (graphic warning labels) sembra diminuire la percezione positiva delle sigarette e aumentare le cognizioni di smettere di fumare nel breve termine (Strong et al., 2021). L’efficacia delle WL è stata testata anche in altri contesti quali bevande non alcoliche e alcoliche, riducendo l’intenzione di acquisto o consumo, e nell’aumentare l’intenzione di limitarne l’assunzione (Bollard et al., 2016; Grummon et al., 2019; Roberto et al., 2016; VanEpps et al., 2016; Wigg & Stafford, 2016). Secondo Clarke et al. (2021), le WL possono ridurre la probabilità di selezionare un prodotto contenente tale etichetta del 26% rispetto ad uno senza. Clarke et al. (2020) hanno sperimentato l’efficacia delle WL anche in prodotti alimentari, ovvero degli snack. Nello specifico, attraverso un messaggio di avvertimento che ricordasse il collegamento tra assunzione di cibi ad alto contenuto di calorie e obesità, e a sua volta tra obesità e cancro dell’intestino. La scelta della barretta energetica nell’esperimento online è passata dal 54% nella condizione in cui erano evidenti solamente le calorie contenute del prodotto, al 38%, quando il prodotto riportava sopra, oltre che al numero di calorie anche un avviso testuale con annessa immagine sugli effetti cancerogeni della merendina. A prescindere dall’utilizzo dell’etichetta come mezzo, così come dalla tematica, fornire delle informazioni e in genere educare le persone relativamente ad un argomento, può avere degli effetti sul cambiamento del loro comportamento (Madajewicz et al., 2007; Snyder et al., 2004; Tummers, 2019; Arlinghaus & Johnston, 2018; Tuong et al., 2014).

Nel contesto della dissuasione del consumo di prodotti ultra-lavorati, le avvertenze nutrizionali possono contrastare la gratificazione immediata di questi prodotti, ricordando ai consumatori i maggiori rischi per la salute e la potenziale perdita della stessa, derivanti dal loro consumo eccessivo
IL DISINCENTIVO DEL CONSUMO
DI CARNE
Concentrandosi sulla letteratura relativa alla
carne, possono essere presi numerosi spunti. Innanzitutto, Bianchi et al. (2018) attraverso la revisione di 24 studi, hanno osservato come generalmente fornire delle informazioni relativamente alle conseguenze salutari e ambientali del consumo di carne sia stato associato a una diminuzione dell’intenzione del suo consumo. Di conseguenza si suggerisce come eventuali campagne di comunicazione potrebbero essere potenzialmente utili, se si dovessero basare su questi aspetti. Cordts et al. (2014) hanno testato l’efficacia, oltre che delle due variabili riportate nell’esperimento sopracitato, anche degli effetti negativi sul benessere animale e sull’immagine sociale di chi consuma carne, riscontrando che solo le tematiche salutari e sugli animali, fossero effettivamente argomenti rilevanti sul problema. PalomoVélez et al. (2018) si sono concentrati sul benessere degli animali, fornendo un saggio sull’argomento e ottenendo risultati analoghi, ovvero un cambiamento nell’attitudine dei partecipanti verso la carne. Ancora, Hunter & Ross (2016), hanno sperimentato invece che il miglior modo per poter influenzare il consumo fosse, oltre ad un’apposita educazione sul tema, anche quello di mostrare eventuali alternative ad essa. Oltre alle informazioni fornite attraverso saggi o articoli scientifici, anche i video
possono essere efficaci (Herchenroeder et al., 2022). Le informazioni sui comportamenti alimentari sostenibili, veicolate da un video, possono influenzare le percezioni dei consumatori nella direzione desiderata (Bschaden et al., 2020). Mathur et al. (2021) hanno infatti utilizzato un documentario per lo stesso scopo, osservando non solo che effettivamente era in grado di diminuire il consumo di carne, ma che l’effetto persisteva anche dodici giorni dopo averlo visto. L’efficacia nel ridurre l’intenzione di consumare carne è influenzata dall’effettiva conoscenza delle sue conseguenze (Hielkema et al., 2021).
Bimbo (2023) ha osservato proprio come coloro che consumano meno frequentemente la carne rossa, siano le persone più consapevoli dell’impatto di essa sul clima, così come questa consapevolezza aumentava la probabilità di ridurre il consumo. Tali dati però non erano validi per le carni bianche. Edenbrandt et al. (2022) complementarmente a Bimbo (2023), hanno visto invece che coloro che acquistano meno prodotti con marchi sostenibili e la maggior parte della carne rossa, sono effettivamente i consumatori che non conoscono i suoi impatti, o hanno una bassa conoscenza in merito. La consapevolezza delle conseguenze, quindi, può ridurre il suo utilizzo. De Boer & Aiking (2022) però ritengono che comunque le persone, ancora reputino altre azioni per il clima con un beneficio potenziale maggiore per l’ambiente rispetto alla carne. Anche la conoscenza delle cattive condizioni in cui si trovano e vengono cresciuti gli animali è associata a un minore con-
distribuzione e consumatori

sumo (Fonseca & Sanchez-Sabate, 2022), così come la salute (Lee & Simpson, 2016; Macdiarmid et al., 2016). La scarsa consapevolezza di ciò che comporta la produzione di carne probabilmente non aiuta a ridurne il consumo. Vi sono stime diverse relativamente alla cognizione delle persone sul tema. Secondo Statista (2021), in Europa, solo una percentuale poco sopra il 10% si trova in accordo con l’affermazione “Pensi che le tue abitudini alimentari possano influenzare negativamente l’ambiente?”. Secondo studi invece condotti in Paesi europei e negli Stati Uniti, la percentuale di soggetti consci del fatto che la carne impatta sull’ambiente oscillava tra il 23% e il 35% (De Boer et al., 2013; De Groeve & Bleys, 2017; Pohjolainen et al., 2016). Allo stesso modo però quando Truelove & Parks (2012) hanno chiesto di nominare comportamenti che contribuissero all’inquinamento, meno del 10% citava il consumo di carne. Scarsi risultati si manifestano anche per l’effettiva conoscenza delle cattive condizioni in cui vertono gli allevamenti e i danni per la salute. In Grummon et al. (2022) la percentuale di consapevolezza tra i partecipanti era dell’8% per la relazione tra il consumo di carne rossa e cancro alla prostata e del 28% per le malattie cardiache. In generale, dunque, è una poca conoscenza che i consumatori hanno di ciò che comportano queste scelte alimentari a far sì che, agli atteggiamenti negativi nei confronti della carne, non corrisponda un egual comportamento di acquisto (Grunert, 2006). Tale affermazione è coerente anche con il modello transteorico del cambiamento di un comportamento sanitario, articolato in tre fasi, di cui la prima è necessariamente la consapevolezza del problema, seguita poi dalla volontà e l’effettivo cambiamento (Glanz, et al., 2008). Esistono alcuni studi che hanno provato a disincentivare il consumo di
carne con le warning label con risultati più o meno incoraggianti. Taillie et al. (2022) hanno sviluppato delle WL a forma ottagonale per la carne, riguardanti il collegamento del consumo di essa con la salute dell’uomo e del suo impatto sull’ambiente. In totale ne hanno testato otto relative alla salute, con messaggi quali “Mangiare la carne rossa aumenta il tuo rischio di sviluppare il diabete, …cancro del colon…, … ictus, …” e dieci sull’ambiente con messaggi quali “Mangiare carne rossa contribuisce al riscaldamento globale, … al cambiamento climatico, … alla deforestazione, …”. Hanno osservato che effettivamente quelle salutari aumentavano l’intenzione di ridurre il consumo di carne; tuttavia, non sono effettivamente state poste sopra dei prodotti e non ne hanno testato l’impatto diretto su di essi. Tale procedura è stata invece fatta da Taillie et al. (2021) che hanno osservato se, l’apposizione di un’etichetta testuale che avvertiva sugli effetti della carne sull’ambiente, o sulla salute, o da una combinazione dei due potesse influenzare la scelta, tra un set di opzioni diverse. In un primo esperimento l’alternativa era relativa a dei burritos, contenenti carne rossa, bianca o piselli. Nel secondo esperimento vi era una combinazione di prodotti di carne lavorata (bacon o salsiccia) o prodotti che contenessero carne (della pizza, un panino, ed un cheese burger). Anche se le etichette con le avvertenze sulla salute hanno effettivamente aiutato i partecipanti a individuare la scelta meno salutare, nessun risultato, anche se nella direzione ipotizzata (riduzione della scelta di alimenti con carne), è risultato essere significativo. Kranzbühler &
Schifferstein (2023) hanno ottenuto invece un esito positivo dal loro studio. Hanno osservato che degli avvertimenti in forma di etichetta sul prodotto, che stimolassero un senso di vergogna verso le proprie azioni (comprare la carne) fossero efficaci nel ridurre l’intenzione di acquisto della carne, e che questa relazione fosse mediata appunto dal senso di colpa e di vergogna provato dai soggetti. Le avvertenze erano relative alla sofferenza degli animali, l’impatto ambientale e i danni potenziali per la salute dell’uomo, con quest’ultimo risultato il meno efficace tra i tre. Koch et al. (2022) hanno studiato l’effetto di mediazione del disgusto sull’intenzione di ridurre il consumo di carne dovuto a delle etichette di avvertenza. Queste ultime, infatti, contenevano delle immagini “forti” quali ad esempio l’interno di un colon canceroso. Le etichette si sono dimostrate efficaci nell’aumentare l’intenzione di ridurre il consumo di carne.
LA PERCEZIONE
DEI CONSUMATORI
DELLE DIVERSE TIPOLOGIE
DI PRODOTTI A BASE DI CARNE
La lavorazione della carne influisce anche sulla percezione qualitativa del prodotto e di conseguenza sulla disponibilità a pagare
Un’ulteriore variabile che si intende indagare è dovuta alla differenza tra il fatto che la carne sia lavorata o meno. È interessante approfondire la tematica più generale relativa alla percezione delle diverse tipologie di carne, in particolare tra carne rossa o bianca, o il caso in cui questa sia processata o meno. Complessivamente l’attitudine nei confronti della carne è estremamente varia (Pfeiler & Egloff a, 2018). Gli atteggiamenti e le convinzioni che le persone hanno nei confronti di prodotti a base di carne dipendono, oltre che dalle variabili intrinseche degli stessi, anche da caratteristiche relative alla singola persona (Font-i-Furnols & Guerrero, 2014). Ciò dipende da variabili demografiche quali ad esempio il sesso (Pfeiler & Egloff, b, 2018) l’età o lo status economico (Gifford & Nilsson, 2014), o psicologiche quali ad esempio i tratti della personalità “Big Five” (Keller & Siegrist, 2015). Basti pensare anche alle diverse attitudini che si riversano sulle abitudini alimentari. Si parla infatti dei vegetariani e vegani che si astengono totalmente dal consumarla (Ruby, 2012), altri che mangiano solo il pesce (Piazza et al., 2015) così come coloro che consumano qualsiasi tipologia di carne. È varia anche l’associazione che viene fatta tra una tipologia e l’altra. Le associazioni più dirette fatte con la carne
rossa sono relative alla mascolinità (Rozin et al., 2012) e alla socialità (Horgan et al., 2019, Leroy & Praet, 2015). La carne bianca e il pesce, invece, vengono fortemente percepiti come alimenti salutari (Clifton & Tapsell, 2013). L’approccio che l’essere umano può avere nei confronti delle diverse tipologie potrebbe essere simile alla differenza di attitudine delle persone nei confronti del consumo della frutta e della verdura (Chapman & Armitage, 2012). Relativamente alle caratteristiche del prodotto invece, ciò che contribuisce maggiormente alla creazione dell’atteggiamento nei suoi confronti e che influenzano le decisioni di acquisto dei consumatori includono tra le altre il contenuto di grassi, il colore (Baba et al., 2016) e la presenza eventuale dell’osso nel taglio (Schulz et al., 2012). Inoltre, le caratteristiche visive vengono utilizzate dai consumatori come suggerimenti per stabilire la qualità del prodotto (Baba et al., 2016) e la presenza eventuale dell’osso nel taglio (Schulz et al., 2012). La lavorazione della carne poi, influisce anche sulla percezione qualitativa del prodotto e di conseguenza sulla disponibilità a pagare. Nello studio di Fernández et al. (2019) qualsiasi tipologia di lavorazione del prodotto ne aumentava il prezzo che i consumatori erano disposti a pagare. Soprattutto la stagionatura era la lavorazione che permetteva un prezzo fino al 129% superiore rispetto ai suoi equivalenti non lavorati. Infine, i prodotti trasformati a base di carne bovina sono stati più apprezzati dei prodotti che non lo erano. Un ulteriore indizio relativo alla diversa percezione può essere ottenuto analizzando la percezione dei suoi sostituti. I consumatori tendono a percepire questi, rispetto alla carne, come due categorie di prodotti diverse Fernández et al. (2019) Solamente nel momento in cui la carne subisce una lavorazione, quale ad esempio la trasformazione in hamburger, allora prodotti alternativi ad essa, ma con le
stesse sembianze, vengono raggruppati congiuntamente (Voordouw et al., 2011; Hoek et al., 2011). Per questi prodotti, quindi, è meglio evitare le associazioni dirette con prodotti tipici a base di carne fresca (Voordouw et al., 2011). Lo studio di Michel et al. (2021) fornisce una conferma in tal senso. Esso analizza le associazioni tra prodotti alternativi della carne e prodotti di carne, i primi hanno una più elevata probabilità di poter sostituire la carne come pasto, tanto più
richiamano la forma e le sembianze di un prodotto di carne processato quale ad esempio dei nuggets, delle polpette o degli hamburger (Michel et al., 2021). Lo stesso avviene anche per i prodotti a base di insetti. Quando questi ultimi infatti sono presentati sottoforma di hamburger, hanno una probabilità maggiore di essere consumati (Lammers et al., 2019). Questo poiché tanto meno ricordano l’origine dell’insetto, tanto più la loro accettazione aumenta (Hartmann et al.,

2015). È interessate poi osservare come in America, ad esempio, anche se negli ultimi anni vi sia una crescente preoccupazione nei confronti della salute pubblica dovuta all’elevato consumo di carne lavorata, quest’ultima, al contrario di quella non processata il cui consumo è diminuito, è in aumento (Zeng et al., 2019). Riprendendo il concetto di disincentivare il consumo, in letteratura, gli studi indagano l’efficacia delle loro iniziative sul consumo, intenzione di consumo/intenzione di ridurre il consumo etc, ma senza verificare se effettivamente tali effetti siano efficaci sia per la carne rossa lavorata che non lavorata. Analizzando per esempio la literature review fatta da Harguess et al. (2020) che comprende 22 paper per un totale di 27 differenti studi non vi sono mai risultati differenziati per tipologia di prodotto. In essi vengono verificati modalità di influenza sul consumo di carne quali ad esempio esposizione ad informazioni sull’effetto negativo della carne che spaziano sulle tre tematiche fino ad ora citate, l’utilizzo di messaggi giornalieri specifici, norme sociali, nudging e al-
È interessate osservare come in America anche se negli ultimi anni vi sia una crescente preoccupazione nei confronti della salute pubblica dovuta all’elevato consumo di carne lavorata, quest’ultima, al contrario di quella non processata il cui consumo è diminuito, è in aumento
tri, ma tale differenza non viene studiata. Alcuni di essi indagano solo una delle due categorie nello specifico, i restanti invece fanno riferimento al consumo di carne in generale senza indagare eventuali differenze basate sulla tipologia di prodotto. La possibilità che vi fosse una distinzione concettuale tra la carne lavorata e non lavorata emergeva già nello studio di Kubberød et al. (2002). Attraverso le interviste di un campione di 30 studenti, si delineava il fatto che nessuno di essi, quando si parlava di carne, faceva riferimento ad essa anche in merito ai prodotti di carne processata. Addirittura, in alcuni casi gli intervistati mostravano difficoltà nell’associare il prodotto all’animale di appartenenza. Più recentemente, un contributo in tale direzione viene da Simons et al. (2018). Durante le loro interviste i ricercatori si sono accorti che effettivamente non esisteva un concetto “universale” di ciò che veniva considerato carne e cosa no. Se effettivamente i prodotti più “freschi” o meno trattati quali ad esempio una bistecca, venivano sempre considerati come carne, alcuni intervistati, quando ripercorrevano il loro consumo settimanale, non menzionavano carne processata quale: hamburger, polpette o salumi nel pane. Allo stesso modo Bimbo (2023) ha riscontrato che, anche se effettivamente vi era correlazione tra la consapevolezza dell’impatto ambientale e un minor consumo di carne rossa, e che tale conoscenza produceva un aumento della probabilità ulteriore di volerne ridurre il consumo nel tempo, questi


Pagine
Un glossario che tratta termini, concetti e definizioni sul mondo della carne
Lo scopo di questo Meat Glossary nasce dall’esigenza di condividere un linguaggio comune a tutti i Tecnologi Alimentari ad ogni livello del settore delle carni fresche e lavorate per studiare, modellare e facilitare le operazioni legate alla trasformazione e produzione degli alimenti a base di carne.
Scritto in lingua inglese per renderlo accessibile a tutti e per creare una fonte di informazioni e interazioni tra i Tecnologi Alimentari di tutto il mondo.
Autori
no De Cesari, Massimo Parisi, Da niele Romano, Sabrina Tondato, Salvatore Velotto
Editore
Le modalità di pagamento verranno comunicate a seguito della richiesta. La spedizione avverrà a pagamento avvenuto. Per info: comunicazione@ecod.it




Nonostante i prodotti surgelati a base di carne facciano ancora pochi volumi rispetto alla categoria dei vegetali e dell’ittico, anche il loro consumo è in aumento e sfrutta le potenzialità di questo comparto che è ormai parte integrante delle nostre abitudini alimentari
A cura del Dott. Giuseppe L. Pastori – Tecnologo Alimentare) e della redazione
Iprodotti surgelati hanno conquistato un posto di rilievo nelle cucine degli italiani, offrendo un’alternativa pratica e di qualità per i pasti quotidiani. Rispetto a preparazioni fresche o pronte da consumare, i prodotti surgelati spesso hanno un prezzo più accessibile perché superando il vincolo della stagionalità (soprattutto le verdure) o contando sull’acquisto e disponibilità di interi lotti di produzione primaria, garantiscono prezzi più stabili che quindi non subiscono aumenti nell’arco dell’anno. Questo li rende una scelta ideale per le famiglie che desiderano pasti sani e gustosi a prezzi contenuti, oltretutto senza il problema di gestire lo scarto che rimane completamente in carico all’industria di trasformazione.
Secondo i dati dello IIAS – Istituto Italiano degli Alimenti Surgelati, realtà associativa operante all’interno dell’Unione Italiana Food, che riunisce i produttori di surgelati di tutte le categorie merceologiche – nel 2022 i consumi in Italia hanno registrato un massimo storico sfiorando il milione di tonnellate (990.713 tonnellate, per la precisione) e che tradotto porta la crescita dei consumi pro capite annuo a 16,8 kg [1]. E pensare che ancora nei primi anni ’80 del
secolo scorso i consumi erano attestati intorno ai 3 kg annui pro capite, considerando che in Italia i primi prodotti surgelati sono stati introdotti nel mercato a partire dagli anni ’60 in concomitanza con l’apertura e la diffusione dei primi supermercati e la vendita a libero servizio. I consumatori italiani hanno iniziato
I primi prodotti surgelati sono stati immessi sul mercato negli Stati Uniti nel 1930. Prodotti congelati erano già presenti ma la loro qualità era pessima, specie una volta scongelati. Il merito di avere risolto questo “inconveniente” va attribuito a Clarence Birdseye [2], un ingegnere e inventore statunitense. Birdseye notò che i pesci catturati durante l’inverno in Canada si mantenevano freschi anche dopo essere stati esposti a temperature molto basse. Birdseye sviluppò quindi un processo di congelamento rapido, chiamato “surgelazione ad aria” o “flash freezing”, che permetteva di mantenere intatta la qualità e la freschezza dei cibi congelati. Fondò la General Seafood Corporation nel 1924 e iniziò a commercializzare prodotti surgelati come pesce, verdure e frutta a partire dal 1930.
a familiarizzare sempre di più con i surgelati, grazie anche all’introduzione di nuove tecnologie di produzione e di una maggiore varietà di merceologie disponibili. Ancora oggi i consumatori italiani apprezzano la praticità e la comodità di avere a disposizione alimenti sani e di qualità sempre freschi nel proprio freezer. Le aziende italiane, da parte loro, in quello stesso periodo hanno cominciato a investire nello sviluppo di prodotti surgelati creando una vasta offerta, a partire da quella di prodotti vegetali e del comparto ittico e introducendo via via nel corso dei decenni successivi primi piatti come le lasagne, se -

Lo scorso anno, IIAS ha pubblicato il suo primo Rapporto Ambientale – il primo in assoluto in Italia dedicato agli alimenti surgelati – per evidenziare come questo comparto metta al centro, e non da oggi, l’impegno al rispetto dell’ambiente, all’uso oculato delle risorse (acqua, energia, materie prime) e alla riduzione delle emissioni inquinanti nell’atmosfera, causa prima dell’emergenza climatica. Nell’ultimo triennio 2019-2021, i risultati ottenuti dalle aziende del settore su questo fronte sono significativi: -10% di CO2 emessa (per un valore di 31.400 tonnellate, pari a più di 350.000 auto che percorrono la tratta Milano-Roma), -4% di uso d’acqua (per un valore di 284.000 m3, equivalenti a più di 3 milioni di docce da 5 minuti) e -2% di utilizzo d’energia elettrica e termica (per un valore di 19.000 MWh, pari al fabbisogno energetico annuo di più di 8.500 famiglie di una o due persone). Risultati positivi, soprattutto se considerati nell’ottica di un settore da sempre all’avanguardia nell’innovazione tecnologica e nell’efficientamento dei processi produttivi.
condi piatti elaborati e molti altri. Da allora, il mercato in Italia è cresciuto costantemente, offrendo una vasta selezione di prodotti tra cui anche quelli a base di carne e altri alimenti di elevata qualità. Oggi, i prodotti surgelati sono ampiamente diffusi nei supermercati italiani (tanto che sono stati creati anche punti vendita, insegne e società distributrici che operano nell’e-commerce e nel “door to door”, completamente dedicate al surgelato)
Secondo i dati dello IIAS – Istituto Italiano degli Alimenti Surgelati, nel 2022 i consumi in Italia hanno registrato un massimo storico sfiorando il milione di tonnellate (990.713 tonnellate, per la precisione) che tradotto porta la crescita dei consumi pro capite annuo a 16,8 kg
e sono considerati una scelta pratica e conveniente per molti consumatori. Le aziende italiane specializzate in questo settore sono costantemente impegnate a offrire una gamma sempre più ampia di prodotti salutari, sostenibili e di alta qualità per incontrare le esigenze dei consumatori.
Il consumo dei surgelati è prevalentemente domestico, anche se l’incidenza del fuori casa che si attesta intorno a quote del 30% genera maggior valore (in calo invece risultano le vendite door to door e e-commerce).
Il boom dei consumi domestici si è avuto in pandemia, ma anche se alla data del rapporto IIAS 2022 si è misurata una leggera flessione, le quantità rimangono importanti. I prodotti che vengono maggiormente consumati nel canale retail sono i vegetali, le cui vendite si sono attestate a quota 208.000 tonnellate (escluse le patate e i vegetali preparati. Le patate surgelate da sole sfiorano quasi le 100.000 tonnellate, mentre l’ittico - preparato panato e pesce naturale - è il terzo comparto più consumato con 94.000 tonnellate. Seguono le pizze e i piatti pron-
ti (al cui interno le lasagne alla bolognese sono il primo prodotto) i cui consumi si attestano intorno alle 65.000 tonnellate ciascuno. Il segmento delle carni vende poco più di 15.000 tonnellate, anche se a dire il vero parliamo solo dei prodotti pronti da cuocere, come hamburger, meat ball, nugget di pollo panati, cordon blue, ecc., senza considerare la carne come ingrediente presente in piatti più elaborati come i primi e i secondi piatti, i sughi e i salumi sulle pizze.
NELLE
DI CONGELAMENTO
Ciò che ha aiutato la diffusione di questo segmento dei “convenience food” surgelati è stata l’evoluzione tecnologica, sia a livello domestico che industriale.
In ambito domestico l’avvento del freezer
(combinato con il frigorifero o come elemento separato) ha rappresentato una vera e propria rivoluzione nella conservazione degli alimenti. Fino ad allora, il mantenimento di cibi a lunga durata richiedeva l’utilizzo di metodi come la salagione, l’essiccazione o l’inscatolamento. Il freezer permette di congelare gli alimenti in casa, con evidenti vantaggi. Innanzitutto, consente di prolungare la durata della conservazione degli alimenti. Il congelamento rallenta o blocca il processo di deterioramento dei cibi, preservandone la freschezza e le proprietà nutritive. In questo modo, è possibile conservare frutta, verdura, carne, pesce e molti altri alimenti per un periodo di tempo più lungo rispetto all’utilizzo del frigorifero. Inoltre, la possibilità di congelare gli alimenti in casa contribuisce ad evitare sprechi. Spesso capita di acquistare una quantità di cibo maggiore rispetto a quanto necessario per un pasto singolo. Congelando l’eccesso, è possibile conservarlo per un utilizzo successivo senza doverlo scartare. Per garantire una corretta conservazione degli alimenti congelati in casa, è importante seguire alcune regole di base. La prima è congelarli il più velocemente possibile, preferibilmente entro poche ore dalla loro preparazione o acquisto. Questo aiuta a preservarne la freschezza e la qualità. È inoltre importante etichettare e datare correttamente gli alimenti congelati, in modo da poterli identificare facilmente e consumarli entro i tempi consigliati. Oggi, i freezer do-


Una rivoluzione tecnologica si è avuta a livello industriale con l’introduzione della tecnica di surgelazione IQF (Individually Quick Frozen) in cui ciascun alimento o unità che lo compone viene congelato velocemente, uno per uno, in modo indipendente dagli altri alimenti presenti nel processo
mestici sono dotati di tecnologie avanzate che consentono di mantenere la temperatura costante e garantire la conservazione nella maniera ottimale: quelli di fascia alta con 3+1 stella (4 stelle) hanno anche la funzione di congelamento rapido che permette di congelare gli alimenti in tempi brevi senza compromettere la loro qualità. L’avvento del freezer domestico ha permesso alle famiglie di congelare sia gli alimenti fatti in casa che di ottimizzare l’acquisto dei prodotti surgelati per fare scorta e averli a portata di mano per tempi più lunghi rispetto al mantenerli nel frigorifero o nel piccolo comparto del ghiaccio che c’era una volta ed era classificato con una sola stella (perché garantiva una temperatura massima -6°C) dove possono durare al massimo per una sola settimana. Grazie alle nuove tecnologie e all’ampia scelta di contenitori specifici per la conservazione in freezer, è oggi possibile congelare e conservare in modo sicuro una varietà di alimenti per periodi più lunghi, garantendo una maggiore durata e conservazione.
Un’altra rivoluzione tecnologica si è avuta a livello industriale, quando è stata introdotta la tecnica di surgelazione IQF (Individually Quick Frozen) che consente di conservare gli alimenti in modo rapido ed efficiente. IQF è una tecnica di congelamento in cui ciascun alimento o unità che lo compone viene congelato velocemente, uno per uno, in modo indipendente dagli altri alimenti presenti
La surgelazione IQF è particolarmente vantaggiosa per gli alimenti delicati, come frutta, verdura, pesce e prodotti da forno, ma è anche adatta a singoli petti di pollo, hamburger, nugget e meat ball, poiché consente loro di mantenere la loro integrità e texture
In linea con i più recenti trend della GDO, Epta presenta la gamma di vasche GranOntario e GranDrake della famiglia GranFit di Costan, con cui dà nuova vita ai surgelati.
Gli orizzontali negativi GranOntario e GranDrake della famiglia GranFit a marchio Costan, rispettivamente a vasca doppia e a vasca singola, permettono la creazione di format di vendita unici nel reparto surgelati di ogni store, che superano gli schemi tradizionali, consentendo di sperimentare layout basati su combinazioni inedite, grazie a volumi espositivi flessibili e personalizzabili.
In un’ottica comparativa rispetto ai modelli precedenti, GranOntario e GranDrake si contraddistinguono per superiore capacità espositiva e stabilità della temperatura interna, a favore del massimo risparmio energetico.
Caposaldo della nuova linea è la trasparenza: la speciale struttura in vetro garantisce il 100% della visibilità dei prodotti esposti, contro il 64% raggiunto dai modelli precedenti, massimizzandone attrattività e reddittività. Il distintivo effetto “total glass”, abbinato alla linea di carico posta a 435 mm e alla riduzione del numero di binari di scorrimento, permette inoltre un incremento dell’8,75% di referenze in esposizione rispetto al modello Tortuga Ultra, a parità di ingombro al suolo. La vetratura panoramica di questi modelli e il mobile di testa dalle forme arrotondate rendono l’estetica di GranOntario e GranDrake perfettamente coordinata con il family feeling della linea GranFit.
I vetri temprati, anticondensa, a basso fattore di riflessione ed emissività sono concepiti inoltre per ridurre la dispersione del freddo e, insieme all’ottimizzazione della rotazione delle ventole digitali a 24V e della resistenza anticondensa sui telai dei vetri, sanciscono il miglioramento della classe energetica da E a D, per una riduzione dei consumi energetici del 24%.
In più, il design minimalista ed ergonomico si declina anche nel dispositivo anti-intrappolamento sulle coperture a spinta e nel corrimano a 860 mm da terra.
nel processo. Questa tecnica è stata introdotta per la prima volta all’incirca nell’ultimo decennio del XX secolo e ha portato notevoli vantaggi rispetto ai metodi tradizionali di surgelazione. Prima dell’introduzione dell’IQF, gli alimenti venivano spesso surgelati in blocchi o pezzi più grandi, il che rendeva difficile congelare e scongelare in modo uniforme il prodotto. Inoltre, il congelamento di grandi quantità di alimenti insieme portava a un aumento di tempo del processo e alla formazione di cristalli di ghiaccio che potevano compromettere la qualità del cibo. Con la tecnica IQF, gli alimenti vengono congelati in modo indipendente, in breve tempo. I singoli ingredienti o elementi di un prodotto ven-

Il film FreezyPeel di ITP ha conquistato la giuria di esperti del Best Packaging 2024, gli Oscar italiani dell’imballaggio organizzati da Istituto Italiano Imballaggio. L’accessibilità e l’ecosostenibilità hanno mosso i ricercatori di ITP nello sviluppo di questo film per surgelati. Si tratta di un monofilm pelabile in polietilene coestruso, che rappresenta un connubio di praticità, sicurezza e sostenibilità, offrendo una nuova prospettiva nel settore del confezionamento alimentare.
Il film è ottenuto per coestrusione con soffiaggio in bolla ed è stampato in flessografia. La combinazione di polietileni di diverse densità e caratteristiche ha consentito di bilanciare la giusta rigidità e la resistenza alla perforazione (caratteristiche in conflitto), di mantenere buone proprietà meccaniche anche alle basse temperature e una brillantezza superficiale che esaltasse eventuali immagini stampate. Il film viene presentato in versione bianca con spessore da 60μm, ma è disponibile anche trasparente e in spessori diversi a seconda del peso del contenuto.
Essendo completamente in polietilene, il film è di fatto un mono materiale riciclabile.
La formulazione dello strato saldante della busta (easy open) è l’aspetto innovativo, perché consente un facile accesso al contenuto senza l’utilizzo di forbici, coltelli, senza troppi sforzi nel lacerare la busta e senza rimozione di bordini (per esempio caso che si verifica con il pretaglio), perché la busta si apre semplicemente tirando i due lembi da parti opposte.
I punti di forza di FreezyPeel:
• Apertura senza forbici. ITP reinventa il concetto di apertura facilitata, permettendo agli utenti di accedere al contenuto tirando semplicemente i due lembi, come per i pacchetti di patatine. Senza pretagli, zip o meccanismi complicati, la soluzione ITP offre un’accessibilità senza precedenti al frozen food.
• Sostenibilità e sicurezza. FreezyPeel è un film monomateriale coestruso, costituito unicamente di polietilene, e quindi riciclabile. ITP si impegna da sempre a fornire soluzioni che rispettino l’ambiente garantendo prestazioni di altissimo livello, per la corretta e salubre conservazione dei cibi.
• Formulazione hi-tech. ITP, da 50 anni leader nel mercato dei film flessibili estrusi in bolla, ha sviluppato il pelabile per surgelati FreezyPeel: la formulazione unica e innovativa garantisce la resistenza necessaria alle basse temperature (-20°C) e una brillantezza superficiale che valorizza le immagini stampate.
gono fatti passare su un nastro trasportatore e sottoposti a flussi d’aria con temperature che possono arrivare a -40°C, di fatto portandoli velocemente allo stato di surgelazione e mantenendoli separati gli uni dagli altri. Questo metodo garantisce che la struttura, il sapore e la qualità nutrizionale degli alimenti siano preservati al massimo, minimizzando la formazione di cristalli di ghiaccio o alterazioni indesiderate. La surgelazione IQF è particolarmente vantaggiosa per gli alimenti delicati, come frutta, verdura, pesce e prodotti da forno, ma è anche adatta a singoli petti di pollo, hamburger, nugget e meat ball, poiché consente loro di mantenere la loro integrità e texture. Inoltre, questa tecnica offre una maggiore praticità in termini di porzionamento e riduzione degli sprechi, poiché gli alimenti possono essere congelati singolarmente senza attaccarsi tra loro.
L’implementazione della surgelazione IQF ha portato a un notevole aumento di efficienza nelle operazioni di congelamento industriale, dal momento che consente di congelare grandi quantità di alimenti in modo rapido e accurato. Ciò ha favorito una maggiore produttività e una migliore gestione delle risorse nel settore alimentare. Inoltre, ha aperto nuove opportunità nel campo della produ-
La surgelazione IQF ha notevolmente migliorato anche la logistica nella catena di distribuzione degli alimenti. I cibi congelati individualmente possono essere facilmente manipolati, trasportati e conservati, senza il rischio di danneggiamenti o problemi di stoccaggio
zione alimentare. Grazie a questa tecnica, è possibile offrire una vasta gamma di alimenti surgelati, già porzionati e pronti all’uso, che mantengono la freschezza e la qualità dei prodotti appena colti o preparati. Ciò ha reso possibile la diffusione di alimenti esotici o fuori stagione, consentendo ai consumatori di godere di una maggiore varietà di scelta. La surgelazione IQF ha notevolmente migliorato anche la logistica nella catena di distribuzione degli alimenti. I cibi congelati individualmente possono essere facilmente manipolati, trasportati e conservati, senza il rischio di danneggiamenti o problemi di stoccaggio.
Il vantaggio di disporre di prodotti surgelati IQF è evidente soprattutto per il consumatore che, all’apertura della confezione, non si trova più a dover gestire un unico blocco surgelato (e che deve cuocere tutto) ma tante singole parti che gli permettono di prelevare e porzionare solo quello che vuole consumare, continuando a conservare il resto. Inoltre anche la cottura è facilitata dato che il calore penetra nell’alimento in modo più omogeneo e diretto, garantendo una perfetta consistenza di tutti gli elementi che compongono il piatto.
C’È DIFFERENZA TRA SURGELAZIONE E CONGELAZIONE?
Nel congelamento e nella surgelazione, gli alimenti vengono raffreddati a temperature che trasformano l’acqua da liquida a solida, formando cristalli di ghiaccio. Questo impedisce ai batteri di crescere e di contribuire al deterioramento degli alimenti, causando potenzialmente intossicazioni o tossinfezioni alimentari. Di conseguenza, il congelamento e la surgelazione ci permettono di conservare gli alimenti per periodi di tempo molto più lunghi rispetto alla refrigerazione
1La scongelazione nel frigorifero – se l’alimento non può essere cotto direttamente in pentola o nel microondeè il metodo più sicuro, in quanto permette di effettuare l’intero processo lentamente, mantenendo gli alimenti a temperature sicure. È sconsigliato scongelare i cibi a temperatura ambiente, in quanto questo favorisce lo sviluppo di batteri. Se l’alimento è confezionato in piccoli blocchi sigillati lo si può anche scongelare in acqua corrente, favorendo un deflusso continuo laminare di acqua o cambiandola ogni 30 minuti.
tradizionale. Durante il congelamento/surgelazione, i batteri rimangono inattivi, cioè non si moltiplicano (ma solo in pochi casi non sopravvivono): congelando, è come se si mettesse in stand by la crescita; scongelando, il processo di crescita dei batteri riprende dal punto in cui si era interrotto (ecco perché è anche importante sapere come scongelare1). Inoltre, il congelamento e la surgelazione riducono l’attività degli enzimi naturalmente presenti in alcuni alimenti, contribuendo a preservare le caratteristiche di freschezza dei prodotti e le loro proprietà nutrizionali.
Da un punto di vista operativo, surgelazione e congelamento sono entrambi metodi di conservazione al freddo, ma tra i due processi ci sono differenze significative.
La carne utilizzata per la preparazione dei prodotti surgelati è attentamente selezionata e sottoposta a severi controlli di provenienza e sicurezza. Questo garantisce una filiera di produzione controllata e trasparente, in cui ogni passaggio è attentamente monitorato per assicurare la salubrità dell’alimento finale
La conservazione mediante surgelazione è un sistema che prevede il rispetto di alcuni parametri stabiliti dalle normative [3,4].
Tra questi vi sono il raggiungimento della temperatura a -18°C al cuore del prodotto in tempi molto brevi, la vendita esclusiva nella confezione originale del produttore e il mantenimento del prodotto ad almeno -18°C lungo tutta la filiera e per tutta la sua vita commerciale. Questo processo rapido, che può essere applicato solo su alimenti di piccole dimensioni, comporta la formazione di microcristalli sia all’interno che all’esterno delle cellule, garantendo così la conservazione della struttura cellulare e dei caratteri organolettici (colore, sapore, odore e consistenza alla masticazione che sono percepite dai nostri sensi), nonché del profilo nutrizionale (come i macronutrienti, le vitamine e i minerali) per diversi mesi, senza sostanziali cambiamenti.
Il congelamento, diversamente dalla surgelazione, non ha tempi e temperature fisse di raffreddamento definite per legge, quindi si possono anche trattare alimenti di grandi dimensioni in blocchi. È un processo di abbassamento della temperatura degli alimenti sotto il punto di congelamento dell’acqua (che è 0°C) e un prodotto congelato si può dire correttamente conservato anche a una temperatura superiore come -12°C (anche se generalmente i prodotti congelati sono conservati a temperature intorno ai -18°C). I tempi di conservazione possono perciò variare in funzione del tipo di alimento e della sua qualità originaria. Se il processo di raffreddamento avviene lentamente (in passa-
to le apparecchiature frigorifere spesso non avevano abbastanza capacità per le dimensioni e il tipo di alimento da congelare), possono formarsi dei macrocristalli nei prodotti congelati che, a causa delle loro dimensioni, possono danneggiare le cellule provocando una parziale perdita della struttura originaria. In questo caso, durante le fasi di scongelamento e cottura possono verificarsi perdite significative di nutrienti e un deterioramento degli aspetti organolettici.
Sta di fatto che il raffreddamento a temperature negative in ambiente domestico mettendo gli alimenti nel freezer, non ha i requisiti della surgelazione ma è solo un processo di congelamento: il raffreddamento dell’ali-



Il “Crust freezing” è un processo di surgelazione in cui un sottile strato esterno di un taglio di carne viene congelato in maniera rapida e uniforme. Questa metodica, per esempio prima dell’affettamento (ma indispensabile anche per il packaging in skin di hamburger e tartare), è diventata preziosa per i trasformatori di carne, perché porta a vantaggi in termini di efficienza, qualità e mantenimento della resa.
La maggiore consistenza del sottile strato esterno della carne congelata, più sodo e stabile rispetto al fresco, dà dei tagli più sottili, più puliti e più netti, e quindi una maggiore uniformità nello spessore e nell’estetica delle fette, essenziale per l’aspetto, accuratezza e costanza del peso delle porzioni.
Anche nei processi di taglio più automatizzati e ad alta velocità, consente una maggiore produttività e costi di manodopera ridotti. Ne preserva l’integrità evitando lacerazioni e garantisce che ogni fetta mantenga la sua forma e una qualità costanti nel tempo. Questo semplifica e ottimizza anche le operazioni di confezionamento e etichettatura. Una qualità di taglio migliore, inoltre, significa meno sprechi, rese più elevate e maggiori profitti.
Il tunnel Ultraflow® di DSI Dantech, di cui
Tech4foods è partner esclusivo per l’Italia, ha un tempo di congelamento estremamente rapido che, unito a cicli di sbrinamento molto distanziati tra loro nel tempo, permette lunghi e ininterrotti periodi di lavoro. Questo è reso possibile da un efficace e veloce flusso d’aria, ad urto (detto impingment) che scorre sopra il prodotto provenendo sia dall’alto e sia dal basso: l’effetto Coanda riprodotto, il principio dell’ala di un aereo, consente un flusso dell’aria tale da avvolgere tutto il prodotto, così da rimuoverne rapidamente ed efficacemente la sua energia, il suo calore. Il congelatore Ultraflow® è disponibile in due versioni.

• Ultraflow® Max è un tunnel isolato da pannelli laterali standard, • mentre Ultraflow® Super Hygiene, unico nel suo genere, è dotato di un isolamento completamente elevabile che libera la parte interna consentendo un accesso più facilitato e pulizia all’interno della struttura.
mento avviene in tempi più lunghi di quanto stabilito dalla normativa per raggiungere la temperatura di -18°C in ogni suo punto (anche con la funzione “fast freezing”).
E LA CARNE?
SOLO PRODOTTI DI QUALITÀ
Un luogo comune voleva che i prodotti surgelati fossero fatti con materie prima di scarsa qualità. In realtà è proprio la legislazione che impone precisi requisiti normativi anche nella selezione delle materie prime, affinché gli alimenti possano venire surgelati ed essere definiti come tali:
• le materie prime usate per la produzione degli alimenti surgelati devono essere di buona qualità, sottoposte ad un trattamento speciale di congelamento, detto appunto “surgelamento”, che “permette di superare con la rapidità necessaria in funzione della natura del prodotto la zona di cristallizzazione massima del prodotto e di far sì che la temperatura del prodotto in tutti i suoi punti – dopo la stabilizzazione termica – sia mantenuta ininterrottamente a valori pari o inferiori a -18°C”;
• una volta pulite, lavorate, formate e/o panate e precotte le varie parti, l’operazione di surgelamento deve essere effettuata senza indugio mediante attrezzature tecniche idonee per ridurre al minimo le modifiche chi-

miche, biochimiche e microbiologiche;
• i mezzi criogeni che si possono utilizzare sono esclusivamente aria, azoto e anidride carbonica;
• gli alimenti surgelati devono essere venduti nelle loro confezioni originali e in etichetta vanno riportate tutte le indicazioni a norma di legge;
• la temperatura degli alimenti surgelati dev’essere stabile e mantenuta in tutti i punti del prodotto a -18°C;
• le materie prime utilizzate nella produzione
SCONGELAMENTO RAPIDO CON LUTETIA®: PRESTAZIONI STRAORDINARIE, TECNOLOGIE VERSATILI

Lo scongelamento dei prodotti a base di carne solitamente è un processo molto lungo, in cui l’alimento congelato perde una parte dei suoi liquidi e delle proteine attive. Le attrezzature Lutetia® sfruttano tecnologie che contrastano la perdita dei succhi della carne. All’interno del tamburo rotante della zangola, la carne congelata viene scongelata in IQF o blocchi mediante iniezione di vapore sottovuoto. Il vantaggio di questa tecnologia consiste nel fatto che i succhi della carne, costituiti da acqua e proteine, restano praticamente inalterati. Grazie alla notevole riduzione della perdita di liquidi, il calo di peso che si verifica con lo scongelamento tradizionale si riduce del 5-10% circa. Allo stesso tempo, questo procedimento riduce la proliferazione dei microbi, aumentando la sicurezza dei prodotti. Lo scongelamento in zangola è quindi ideale per la successiva cottura o marinatura dei prodotti.
Come complemento allo scongelamento in zangola, Lutetia® ha sviluppato una nuova tecnologia che risponde alla perfezione alle esigenze dei clienti: lo scongelamento in camera. La tecnologia brevettata di convezione all’interno della camera assicura un flusso d’aria elevato con umidità satura. Questo la rende ideale per i prodotti delicati come pesce, pollame, carne di manzo, maiale, arista di maiale e agnello, che devono semplicemente essere scongelati “come freschi”.
In aggiunta alla vasta gamma di impianti Lutetia®, queste due tecnologie – scongelamento in zangola e camera - rispondono perfettamente alle esigenze dei clienti sia per i prodotti freschi che per quelli destinati alla successiva lavorazione.
Le aziende che producono surgelati devono rispettare le norme dell’HACCP (Hazard Analysis and Critical Control Points), il sistema di gestione che identifica, valuta e controlla i pericoli che possono influire sulla sicurezza degli alimenti
degli alimenti surgelati composti possono essere sottoposte ad un precedente trattamento di conservazione e contenere additivi nei limiti stabiliti dai decreti ministeriali.
I vegetali possono essere sottoposti, prima della surgelazione, a un leggero trattamento termico (“blanching”) che fissa il colore e inattiva gli enzimi che potrebbero alterare la qualità.
Il pesce in genere viene surgelato sulle imbarcazioni che lo hanno pescato oppure è trasportato a terra refrigerato per essere lavorato e surgelato immediatamente in appositi laboratori.
La carne utilizzata per la preparazione dei prodotti surgelati è attentamente selezionata e sottoposta a severi controlli di provenienza e sicurezza. Questo garantisce una filiera di produzione controllata e trasparente, in cui ogni passaggio è attentamente monitorato per assicurare la salubrità dell’alimento finale. La produzione può essere orientata a fornire sia referenze crude da cuocere come hamburger di bovino o di pollo, macinato, braciole e bistecche, sia prodotti elaborati panati come nuggets di pollo, cotolette, cordon blue, sia hamburger, salsicce e spiedini già parzialmente grigliati e solo da far rinvenire in pochi minuti anche nel microonde. O, ancora, preparare polpette di ogni tipo per creare ricette anche personalizzate. Il fatto che tutta la produzione venga oggi abbattuta con la tecnologia di surgelazione IQF,

fa sì che i singoli preparati non si attacchino tra loro, favorendo la porzionatura, la facilità di preparazione e il servizio, non solo per il consumo domestico ma anche per tutto ciò che si utilizza nel canale Ho.Re.Ca (Hotellerie, Restaurant & Café), che comprende tutto il mondo legato a consumi e somministrazione di cibi e bevande che non è fatto tra le mura di casa: ristoranti gourmet, snack bar, food truck, catering, con mense e ristorazione collettiva, ecc.
Un aspetto fondamentale da sottolineare riguarda la sicurezza alimentare. Le aziende che producono surgelati devono rispettare le norme dell’HACCP (Hazard Analysis and Critical Control Points), il sistema di gestione che identifica, valuta e controlla i pericoli che possono influire sulla sicurezza degli alimenti. Questo significa che ogni fase del processo produttivo, dalla produzione alla distribuzione, viene attentamente monitorata per garantire la massima sicurezza.
Le aziende italiane si impegnano costantemente per garantire l’utilizzo di materie prime di alta qualità: tutte monitorano sia l’origine sia il processo di produzione dei loro ingredienti e semilavorati.
Un altro aspetto positivo dei prodotti surgelati è la loro sostenibilità. Le realtà del settore sono sempre più attente a ridurre l’impatto ambientale della propria produzione, diminuendo l’impiego di energia (e la tecnologia
IQF va in questa direzione) tramite l’autoproduzione, i consumi d’acqua, utilizzando energia elettrica da fonti rinnovabili o ottenuta tramite la cogenerazione o la trigenerazione (cioè la produzione contemporanea di energia elettrica, termica e frigorifera). Molte aziende utilizzano imballaggi eco-sostenibili che riducono l’utilizzo di plastica e promuovono il riciclo.
Il paradosso della vita moderna, nei paesi più ricchi e urbanizzati come il nostro, è quello di acquistare prodotti in eccesso e di sprecare cibo che non consumiamo o di lasciarlo deperire. Se a livello domestico sono soprattutto gli alimenti freschi a finire nella spazzatura o al massimo ad essere destinati al compostaggio, anche i pasti fuori casa vengono spesso non consumati totalmente.
I prodotti surgelati per loro natura sono meno soggetti allo spreco, grazie ad alcune delle loro qualità intrinseche:
- la lunga durata di conservazione che consente di utilizzarli prima che possano scadere o deteriorarsi;
- l’impiego della tecnologia IQF nella surgelazione permette un maggiore controllo delle porzioni e delle quantità, utilizzando solo ciò di cui si ha bisogno e continuando a conservare nel freezer quello che rimane per consumi futuri;
- i prodotti che si acquistano sono già pronti al consumo: i vegetali non devono essere sbucciati, il pesce spinato, taluni prodotti si presentano già precotti e richiedono meno tempo per la cottura;
- tutti gli alimenti sono già puliti e/o lavati: non c’è bisogno di consumare l’acqua di casa;
- tutti gli scarti di produzione sono gestiti direttamente dalle industrie di trasformazione e produzione che li possono destinare come sottoprodotti ad altri scopi (come ad esempio all’alimentazione animale).
Non ultimo, potendo lavorare grandi lotti di prodotto, i surgelati mantengono un elevato potere d’acquisto, stabilizzando i prezzi ed evitando aumenti fuori controllo.
Il Gruppo Siad si impegna nell’offrire soluzioni innovative e sostenibili per i trasporti refrigerati al fine di garantire una corretta conservazione dei prodotti deperibili lungo l’intera filiera. Contrariamente ai sistemi di refrigerazione tradizionali, che utilizzano gas refrigeranti fluorurati ad alto impatto ambientale, Siad ha sviluppato due nuove tecnologie, Coool® - FreeToGo e RollBox, dedicate al settore della logistica. Queste tecnologie mirano a ridurre l’impronta carbonica delle attività di trasporto refrigerato utilizzando CO2 biogenica o recuperata da scarti industriali, in linea con il concetto di economia circolare. Coool® - FreeToGo è un sistema di trasporto refrigerato su gomma che sfrutta il potere frigorigeno della CO2 R-744. Questo sistema offre numerosi vantaggi, tra cui prestazioni superiori rispetto ai sistemi tradizionali, con una maggiore velocità e durata nel mantenimento delle temperature. Inoltre, il sistema è compatibile con diversi mezzi di trasporto e casse isotermiche. Si distingue per la sua ecosostenibilità e risponde alle richieste della Commissione Europea in termini di abbattimento delle emissioni. Inoltre, il sistema Coool® - FreeToGo è silenzioso e indipendente, in quanto rimane attivo anche a motore spento.
Sebbene la tecnologia di surgelazione IQF sia un processo di conservazione molto consolidato che consente di produrre alimenti di alta qualità e con lunga durata di conservazione, la ricerca per migliorare le condizioni di congelamento non si fermano. Le attività sono orientate a trovare processi ancora più innovativi [5]: alcune mirano a migliorare la qualità del prodotto attraverso il congelamento ultrarapido, altre la controllano riducendo la formazione di ghiaccio. Tutte le applicazioni sono volte a proteggere la qualità dell’alimento, consentendo di ridurre la quantità di materiale scongelato o del prodotto finale.
1. IIAS – Istituto Italiano Alimenti Surgelati (2022). I consumi dei prodotti surgelati – Rapporto 2022. https://www.istitutosurgelati.it/wp-content/uploads/2023/07/IIAS_REPORT_CONSUMI_2022.pdf
2. Michael Ruhlman (2017). Brrrr. The Secret History of Frozen. In Wired – US edition, May 19, 2017. https://www.wired.com/2017/05/brrrr-secret-history-frozen-food/ Consultato online il 20 maggio 2024
3. D. Lgs. n. 110 del 27/1/1992 - Attuazione della direttiva 89/108/CEE in materia di alimenti surgelati destinati all’alimentazione umana.
4. Direttiva del Consiglio del 21 dicembre 1988 per il ravvicinamento delle legislazioni degli Stati membri sugli alimenti surgelati destinati all’alimentazione umana. (89/108/CEE)
5. James C., Purnell G., James S.J. (2015). A Review of Novel and Innovative Food Freezing Technologies. Food Bioprocess Technol 8, 1616–1634 https://doi.org/10.1007/s11947-015-1542-8

Surgelazione e congelamento sono trattamenti diversi ed i termini non possono considerarsi sinonimi sebbene LA SURGELAZIONE SIA LEGISLATIVAMENTE DEFINITA COME UN PROCESSO SPECIALE DI CONGELAMENTO, che permette di superare con la rapidità necessaria, in funzione della natura del prodotto, la zona di cristallizzazione massima e di mantenere la temperatura del prodotto in tutti i suoi punti, dopo la stabilizzazione termica, ininterrottamente a valori pari o inferiori a -18 °C.
A livello normativo non esiste una specifica disciplina sui prodotti congelati mentre i surgelati trovano la loro fonte di regolamentazione nel D.lvo 110/1992 che costituisce l’attuazione nazionale della Direttiva 89/108/ CEE sulla produzione, la distribuzione e la vendita degli alimenti surgelati destinati all’alimentazione umana. Si tratta pertanto di una disciplina armonizzata a livello di Unione Europea.
La vigente normativa in materia di surgelati dispone che:
- le materie prime destinate alla produzione di alimenti surgelati devono essere sane, in buone condizioni igieniche, di adeguata qualità merceologica e devono avere il necessario grado di freschezza,
- la preparazione dei prodotti da surgelare e l’operazione di surgelazione devono essere effettuate senza indugio mediante attrezzature tecniche tali da contenere al minimo le modifiche chimiche, biochimiche e microbiologiche, - nella produzione degli alimenti surgelati composti è consentita l’aggiunta di additivi, ivi compresi gli antiossidanti con esclusione degli additivi conservanti, nelle quantità massime stabilite, per i corrispondenti prodotti non surgelati, dal Regolamento 1333/2008, - la temperatura degli alimenti surgelati deve essere mantenuta in tutti i punti del prodotto ad un valore pari o inferiore a -18 °C. Sono tuttavia tollerate brevi fluttuazioni verso l’alto durante il trasporto e durante la distribuzione locale e negli armadi e nei banchi frigoriferi per la vendita al consumatore,
- gli alimenti surgelati destinati al consumatore devono essere venduti in confezioni originali chiuse dal fabbricante o dal confezionatore e preparate con materiale idoneo a proteggere il prodotto dalle contaminazioni microbiche o di altro genere e dalla disidratazione.
Sul versante etichettatura, oltre alle indicazioni previste dalla normativa trasversale ap-
plicabile alla generalità degli alimenti di cui al Reg. 1169/2011 ed alle eventuali norme verticali di settore applicabili allo specifico prodotto, è previsto che la denominazione di vendita, legale, usuale o descrittiva che sia, deve essere completata dal termine “surgelato”.
In etichetta deve essere inoltre riportato: - il termine minimo di conservazione completato dalla indicazione del periodo in cui il prodotto può essere conservato presso il consumatore;
- le istruzioni relative alla conservazione del prodotto dopo l’acquisto completate dalla indicazione della temperatura di conservazione o dell’attrezzatura richiesta per la conservazione; - l’avvertenza che il prodotto, una volta scongelato, non deve essere ricongelato e le eventuali istruzioni per l’uso; - l’indicazione del lotto.
Tali disposizioni si applicano anche agli alimenti surgelati destinati ai ristoranti, agli ospedali, alle mense ed altre collettività analoghe.
La differenza tra i due processi è stata messa in risalto da quanto previsto nell’allegato VI del Regolamento comunitario 1169/2011 in materia di informazioni sugli alimenti ai consumatori recante “denominazione degli
alimenti e indicazioni specifiche che la accompagnano” ai sensi del quale:
“1. La denominazione dell’alimento comprende o è accompagnata da un’indicazione dello stato fisico nel quale si trova il prodotto o dello specifico trattamento che esso ha subito (ad esempio «in polvere», «ricongelato», «liofilizzato», «surgelato», «concentrato», «affumicato»), nel caso in cui l’omissione di tale informazione potrebbe indurre in errore l’acquirente.
2. Nel caso di alimenti che sono stati congelati prima della vendita e sono venduti decongelati, la denominazione dell’alimento è accompagnata dalla designazione «decongelato».
Tale obbligo non si applica:
a) agli ingredienti presenti nel prodotto finale;
b) agli alimenti per i quali il congelamento costituisce una fase tecnologicamente necessaria del processo di produzione;
c) agli alimenti sui quali lo scongelamento non produce effetti negativi in termini di sicurezza o qualità”.
Tale disposizione non è stata ulteriormente specificata dal legislatore soprattutto per ciò che concerne la lettera c) che appare generica e non individua casi specifici.
L’unico elemento di valutazione è presente nel considerando n. 28 del Reg. CE 1169/2011 in cui si rileva che “nel corso degli ultimi decenni la tecnologia per congelare gli alimenti ha compiuto progressi rilevanti ed è diventata di uso comune …. Tuttavia il congelamento e il successivo decongelamento di taluni alimenti, specialmente prodotti a base di carne e pesce, limitano le utilizzazioni successive e possono avere effetti sulla sicurezza e sulle caratteristi-
che organolettiche e fisiche dell’alimento. In altri prodotti, specialmente il burro, il congelamento non presenta invece simili effetti. Di conseguenza il consumatore finale dovrebbe essere informato correttamente sul fatto che si tratta di un prodotto decongelato“. Sempre in tema di prodotti congelati l’art. 10 del citato Regolamento Ue 11699/11 in relazione alle Indicazioni obbligatorie complementari per tipi o categorie specifici di alimenti dispone che, oltre alle indicazioni previste dalla normativa trasversale e verticale di settore, le carni e le preparazioni di carni congelate così come i prodotti della pesca non trasformati congelati devono riportare in etichetta la data di congelamento o la data del primo congelamento per i prodotti che sono stati congelati più di una volta.
La data di congelamento o la data di primo congelamento deve essere indicata nel modo seguente:
a) è preceduta dall’espressione «Congelato il …»;
b) le espressioni di cui alla lettera a) sono accompagnate:
— dalla data stessa, oppure
— dall’indicazione del punto in cui essa è indicata sull’etichetta; c) la data comprende, nell’ordine e in forma chiara, il giorno, il mese e l’anno.
A tal proposito si segnala che nella Comunicazione della Commissione relativa alle domande e risposte sull’applicazione del regolamento (UE) n. 1169/2011 relativo alla fornitura di informazioni sugli alimenti ai consumatori 2018/C 196/01, alla domanda “La data di congelamento o di primo congelamento (se il prodotto è stato congelato più
di una volta) deve figurare obbligatoriamente sull’etichettatura delle carni congelate, preparati di carni congelate e prodotti della pesca non trasformati congelati non preimballati?” è fornita la seguente risposta: “No, la data di congelamento o di primo congelamento è solo obbligatoria sull’etichettatura delle carni congelate, preparati di carni congelate e prodotti della pesca non trasformati congelati che sono preimballati. Gli Stati membri possono decidere di estendere questo obbligo ai prodotti non preimballati”.
È stata inoltre negata la possibilità di utilizzare l’indicazione «Surgelato il [DATA]» per indicare la data di congelamento di carne, preparazioni a base di carne e prodotti non trasformati a base di pesce congelati in quanto l’allegato X prevede espressamente che il termine da utilizzare è «Congelato il …».
Si ricorda infine che, sul piano normativo, il problema dello scongelamento è considerato anche dalla normativa igienico-sanitaria. Il capitolo IX, paragrafo 7, dell’Allegato II al Regolamento (CE) n. 852/2004, così recita: “Lo scongelamento dei prodotti alimentari deve essere effettuato in modo tale da ridurre al minimo il rischio di proliferazione di microrganismi patogeni o la formazione di tossine. Nel corso dello scongelamento, gli alimenti devono essere sottoposti a temperature che non comportino rischi per la salute. Qualora il liquido proveniente dal processo di scongelamento possa costituire un rischio per la salute, esso deve essere adeguatamente allontanato. Dopo lo scongelamento, gli alimenti devono essere manipolati in maniera da ridurre al minimo il rischio di proliferazione di microrganismi patogeni o la formazione di tossine”.
Gli autori sono responsabili delle opinioni espresse negli articoli e delle relative bibliografie

aziende e informatica

M-ERP CSB-SYSTEM
Grazie ad applicativi mobili, è oggi possibile per chiunque ottimizzare il proprio lavoro. Lavorare fuori e dentro lo stabilimento, sempre e ovunque, richiamare tutte le informazioni necessarie allo svolgimento dei vari processi di filiera: con l’MERP del CSB-System è possibile. I dati vengono inseriti online e messi a disposizione dell’ERP centrale in maniera diretta, mobile, flessibile ed efficiente. Con la soluzione M-ERP di CSBSystem i processi diventeranno più efficienti, favorendo decisioni più veloci e attendibili.
EFFICIENZA CON L’M-ERP
A prescindere dal dove e quando, tramite CSB M-ERP che funziona sia con applicativi Windows che Android, l’utente è in grado di rilevare ed elaborare i dati di qualsiasi processo dove questi si generano. I dati sono così comunicati direttamente
all’ERP centrale, con conseguente risparmio di tempo e riduzione degli errori.
CSB M-ERP PER IL RICEVIMENTO MERCI
Con le proposte di acquisto predisposte centralmente nell’ERP
CSB-System, viene supportato l’intero processo dall’articolo per fornitore fino al controllo dell’arrivo della merce. Con la gestione mobile degli ordini di acquisto, è possibile, per esempio, riordinare gli articoli dei punti vendita aziendali direttamente tra le corsie, e ricevere le forniture in completa mobilità, ottimizzando tempi e controlli.
All’interno delle procedure di ricevimento merci sono integrati gli eventuali controlli qualitativi necessari, ottimizzando quindi l’operatività degli utenti interessati.
CSB M-ERP
PER IL MAGAZZINO
L’impiego più celebre di M-ERP è sicuramente la gestione automatizzata, rapida e attendibile
dell’intera movimentazione di magazzino, non solo tutti gli ordini di carico e scarico ma anche la gestione degli inventari. Informazioni chiare, sempre disponibili, sempre aggiornate. Inoltre, grazie a procedure flessibili e facili da usare si riducono al minimo gli errori e i tempi di formazione del personale. Un classico esempio può essere la funzione relativa all’approvvigionamento dei buffer di produzione o dell’area picking. Attraverso i dati di fabbisogno in area vendita e produzione, il sistema in automatico genera degli ordini di movimentazione (i cosiddetti abbassamenti) in maniera da velocizzare la preparazione di materie prime e merci, utilizzando logiche di ottimizzazione in base a percorsi all’interno del magazzino e/o date di scadenza e tracciabilità.
CSB M-ERP
PER PICKING E VENDITA
L’utilizzo di una soluzione mobile consente di ridurre il dispendio di tempo e i margini di
errore nell’evasione degli ordini, con percorsi ottimizzati e verifica online delle richieste specifiche del cliente (ad es. consegna con scadenza minima non infe -

I dispositivi mobili per l’acquisizione dei dati rendono i processi più veloci e i dati disponibili ovunque

riore a tre mesi) e rilevazione uscita merci. Le procedure di preparazione ordini, semplici da usare ma allo stesso tempo flessibili e complete, semplificano la routine lavorativa, alleggerendo lo stress dei periodi di superlavoro. Con la sola introduzione dell’M-ERP in picking e vendita, si incide positivamente su mobilità, controllo e produttività.
CSB M-ERP
PER LA PRODUZIONE
Attraverso il collegamento delle bilance, degli scanner e di tutte le periferiche necessarie, sulla base delle ricette inserite e degli ordini di produzione esistenti, si possono ricomporre gli ingredienti di una ricetta, le cui quantità vengono scaricate dai conti di giacenza di magazzino. La completa ottimizzazione dell’operatività in produzione potrebbe essere riassunta in tre parole: flessibilità, velocità e controllo. Il valore aggiunto deriva da dati sempre aggiornati in tempo reale e sempre corretti, e dalla versatilità degli strumenti proposti che si adattano alle procedure operative presenti in impianto. Aspetto
molto utile per avere performance migliori anche nelle vendite.
PER CONCLUDERE
Avere un unico fornitore di ERP e M-ERP è sicuramente conveniente, perché consente all’azienda di formare gli utenti su un unico software e di avere un
unico referente per le soluzioni sia fisse che mobili. In breve, i vantaggi:
Inserimento e visualizzazione delle informazioni in tempo reale
Integrazione di periferiche per automatizzazione parziale o completa di processi aziendali complessi
Eliminazione del cartaceo
Riduzione degli sprechi di tempo causati da doppi inserimenti
Ottimizzazione delle prestazioni delle risorse umane sull’intera filiera.
Referente CSB-System: Andrè Muehlberger, Direttore CSB-System S.r.l. www.csb.com

Il mio ERP. Così ho tutto sotto controllo.
Efficienza, trasparenza, flessibilità – questo è ciò che conta ora. L’IT è la chiave per ottenerlo. Che si tratti di ERP, MES, macellazione e sezionamento o di software per la pianificazione intelligente: il CSB-System è la soluzione completa per le aziende del settore Carne. Così già oggi potete ottimizzare la vostra produzione e domani digitalizzerete l’intera azienda. Per saperne di più sulle nostre soluzioni per il settore Carne: www.csb.com

La rubrica “Chiedetelo a…” è uno spazio attraverso il quale i nostri lettori (ma anche la redazione stessa) possono avere risposte ad argomenti di diversa natura. Le domande devono essere inviate all’indirizzo email redazione@ecod.it
I quesiti proposti saranno evasi da persone competenti negli specifici settori.

Degli imballaggi con cui si confezionano i prodotti alimentari comprati a libero servizio credo di conoscere abbastanza (e poi ci sono le informazioni in etichetta per smaltirli). Ma gli involucri di carta con cui si impacchettano carni, affettati e alimenti deperibili acquistati al banco taglio come si gestiscono? Quali caratteristiche devono avere e quali leggi li regolamentano?
Quando andiamo a fare la spesa alimentare, tanto negli esercizi commerciali delle insegne della grande distribuzione quanto nei negozi tradizionali (di macelleria, salumeria, panetteria, ecc.), abbiamo due opzioni di scelta: acquistare alimenti già confezionati che troviamo nei lineari e nei frigoriferi di libero servizio oppure farceli servire in porzioni, tranci e affettati ai rispettivi banchi dove personale addetto o specialisti di prodotto (spesso i titolari degli stessi negozi) preparano al momento il taglio fresco in base alle quantità richieste. Sebbene in passato (si parla di 50-60 anni fa) fosse ancora possibile acquistare alimenti sfusi – soprattutto prodotti secchi e stabilizzati come pasta, legumi, caffè in grani e altro – e questa modalità di acquisto è tornata di “moda” oggi (specie per i prodotti non alimentari) in chiave ecologica per ridurre l’impatto ambientale delle plastiche, siamo ormai abituati a considerare il packaging dei cibi di qualunque materiale si tratti (vasetti di vetro, barattoli di plastica, lattine in metallo, astucci di cartone, confezioni in polimeri plastici termosaldati sottovuoto o in atmosfera modificata) come necessario per proteggere gli alimenti e garantire il loro stato igienico, mantenere le qualità organolettiche e sensoriali, preservarli dalla deperibilità e conservarli in modo adeguato.
DEL PRODOTTO
Nel caso di prodotti confezionati industrialmente, siamo tenuti a considerare la confezione come un elemento importante per la conservazione del prodotto, perché ne garantisce la freschezza e la qualità in funzione della sua TMC. Apprezziamo un packaging ben strutturato e resistente, che protegga il contenuto da eventuali danni durante il trasporto e lo mantenga integro fino al consumo. Inoltre anche grazie alle campagne di sensibilizzazione finalizzate al recupero dei materiali e alla raccolta differenziata, con l’introduzione dell’etichettatura ambientale abbiamo imparato a comprendere il significato di alcuni simboli e pittogrammi presenti sui contenitori per uso alimentare, che forniscono chiare indicazioni sul loro stato e sul loro corretto smaltimento.
Per l’acquisto di prodotti freschi come affettati serviti al banco taglio di una salumeria e macelleria o sfusi come il pane, consideriamo il packaging come un elemento meno importante. In questo caso, come consumatori valutiamo principalmente la qualità e la freschezza del prodotto, che per gli alimenti deperibili vuol dire un consumo entro 3-4 giorni o poco più se conservati correttamente nel loro
involucro in frigorifero. Tuttavia gli involucri salva-freschezza di carta che vengono offerti oggi non servono solo a facilitare il trasporto a casa, ma assolvono alle stesse funzioni del packaging industriale: proteggono il prodotto dalla contaminazione esterna creando una barriera nei confronti dell’ambiente circostante, riducendo il rischio di contaminazione; mantengono la freschezza dell’alimento garantendo una corretta umidità all’interno, evitando così che si secchi e rimanga fresco più a lungo; preservano le qualità organolettiche mantenendo intatti il sapore e la consistenza dei prodotti; hanno anche proprietà barriera contro gli effetti dannosi della luce e contribuiscono a ridurre gli sprechi di cibo. Se le funzioni degli imballaggi sono le medesime e quelle appena enunciate sono pertanto le caratteristiche comuni, che cosa garantisce la conformità di ciascun materiale? E quali sono i regolamenti che li definiscono?
Gli involucri salva-freschezza di carta che vengono offerti oggi non servono solo a facilitare il trasporto a casa, ma assolvono alle stesse funzioni del packaging industriale
CHE COSA GARANTISCE
LA CONFORMITÀ DI CIASCUN MATERIALE? E QUALI SONO I REGOLAMENTI
CHE LI DEFINISCONO?
Il primo aspetto da considerare quando si parla nello specifico di packaging alimentare è l’idoneità dei materiali al contatto con gli alimenti affinché siano sicuri. Devono offrire garanzia di non rilasciare sostanze nocive per la salute umana tali da metterla in pericolo e di non causare alterazioni organolettiche nella composizione, nel sapore e nell’odore degli alimenti. Per riconoscere un packaging idoneo, sicuro e sostenibile occorre controllare e conoscere il significato di alcuni simboli, marchi e diciture che vengono impressi o sono stampati sui materiali.
Nello specifico gli imballaggi (al pari di utensili da cucina e da tavolo, recipienti e contenitori, macchinari per la trasformazione degli alimenti, ecc.) sono definiti “materiali ed oggetti a contatto con gli alimenti” (MOCA) e sono disciplinati sia da provvedimenti europei che nazionali. A livello europeo gli imballaggi devono rispettare i dettami del Regolamento (CE) n. 1935/2004 (legge quadro) che stabilisce i requisiti generali cui devono rispondere tutti i materiali e gli oggetti in questione. Tuttavia è bene ricordare che anche questo regolamento non è disgiunto da quelli che regolano le norme in materia igienico-sanitaria e di sicurezza degli alimenti che trovano il loro fondamento nel Regolamento (CE) n. 178/2002, che costituisce la General Food Law, pone i principi e i requisiti generali della legislazione alimentare e istituisce l’EFSA (Autorità Europea per la Sicurezza Alimentare). È per questo che tra le industrie del packaging e dei materiali e quelle della produzione alimentare e della distribuzione esiste uno stretto legame per ga-
In Italia si applica il Decreto Ministro Sanità del 21 marzo 1973 (e successive modifiche e integrazioni) che disciplina materiali a contatto con gli alimenti come gomma, cellulosa rigenerata, carta e cartone, vetro e acciaio inossidabile
rantire l’impiego di materiali adeguati per conservare nelle migliori condizioni igie-
niche e di salubrità i prodotti alimentari. Inoltre trova applicazione il Regolamento (CE) n. 2023/2006 che descrive le buone pratiche di fabbricazione di materiali e articoli destinati al contatto con gli alimenti, mentre i controlli sulla idoneità e conformità alimentare (compresa la salubrità) sono pertinenza ora del Regolamento (UE) n. 625/2017.
Tuttavia, a parte i principi di carattere generale, la normativa comunitaria dispone

Scegli Zudek. La refrigerazione all’avanguardia.
www.zudek.com sales@zudek.com
Progettiamo e costruiamo impianti frigoriferi ad alta tecnologia utilizzando l’ammoniaca come refrigerante.
I nostri prodotti garantiscono risparmio energetico, efficienza, sicurezza e rispondono ad elevati standard di automazione.

di specifiche dettagliate solo di alcuni singoli materiali (ceramiche, pellicola di cellulosa rigenerata, materiali attivi e intelligenti, plastiche e plastiche riciclate) tralasciando di intervenire su molti altri. La misura più completa è il regolamento dell’UE sui materiali e gli oggetti di plastica, il Regolamento (UE) n. 10/2011, che descrive le norme sulla composizione dei MOCA di plastica, compresa l’istituzione di un elenco dell’Unione di sostanze autorizzate nella loro fabbricazione. Perciò laddove non esistono riferimenti europei, in particolare per materiali di carta e cartone, metallo, vetro e inchiostri da stampa, gli Stati membri possono stabilire misure nazionali, che la Commissione europea considera valide se rispondono ai criteri dei principi generali.
In Italia si applica il Decreto Ministro Sanità del 21 marzo 1973 (e successive modifiche e integrazioni) che disciplina altri materiali a contatto con gli alimenti come gomma, cellulosa rigenerata, carta e cartone, vetro e acciaio inossidabile.
Per alcuni di questi materiali sono anche disponibili delle linee guida redatte da Istituti e Organismi di controllo che, seppur non ufficiali e non vincolanti, sono un utile riferimento per tutti i produttori di MOCA.
LA LEGISLAZIONE ITALIANA
PRECISA CHE…
Per quanto riguarda carta e cartone a contatto con gli alimenti, che sono uno dei materiali più usati nell’ambito della vendita al dettaglio e per il confezionamento di alimenti secchi, la legislazione italiana – che è più precisa di quella europea – stabilisce i criteri di composizione della
Tra le linee guida redatte da Istituti e Organismi di controllo disponibili in italiano si può segnalare:
- Istituto Superiore di Sanità – Progetto CAST (Contatto Alimentare Sicurezza e Tecnologia). Linee guida per l’applicazione del Regolamento 2023/2006/CE alla filiera dei materiali e oggetti destinati al contatto con gli alimenti. (https://www.iss.it/documents/20126/45616/09_33_web.pdf/2fe39980-3362-181aacf2-d87fcdbebb13?t=1581098604203)
- Istituto Superiore di Sanità – Progetto CAST. Linee guida per il riscontro documentale sull’applicazione del Regolamento (CE) n. 2023/2006. (https://www.iss.it/documents/20126/45616/13_14_web.pdf/acf21c86-b3e3-cdefbde2-087f736e6ffb?t=1581098907063)
- Istituto Superiore di Sanità – Progetto CAST. Linee guida sulla documentazione di supporto per la dichiarazione di conformità alla legislazione sui materiali e oggetti a contatto con alimenti. (https://www.iss.it/documents/20126/45616/18_24_ web.pdf/03932d51-b003-65f1-3972-748c28b0581e?t=1581099419247)
- CEPI / CIPTA – Linee Guida dell’industria per la Conformità di Materiali e Oggetti di Carta e Cartone destinati al Contatto con gli Alimenti. ( https://www.citpa-europe.org/sites/default/files/Industry%20guideline-updated 2012italian.pdf)
- GIFASP - Linee guida dell’industria per la Conformità di Materiali e Oggetti di Carta e Cartone destinati al Contatto con gli Alimenti. (https://gifasp.it/wp-content/ uploads/sites/4/2021/10/Food-Contact-Industry-Guidelines_2019_final_IT.pdf)
- Provincia Autonoma di Trento – Dip. di Prevenzione U.O. Igiene e Sanità pubblica. Linee guida per il controllo ufficiale sui materiali ed oggetti destinati a venire a contatto con gli alimenti (https://www.apss.tn.it/Documenti-e-dati/Documenti-tecnici/Linee-guida-per-il-controllo-ufficiale-sui-materiali-e-oggetti-destinati-a-venirein-contatto-con-gli-alimenti#)
carta in funzione del tipo di alimento, che sia utilizzata da sola o accoppiata con altri materiali (es. la carta politenata, dove è il film di polietilene quello a contatto con l’alimento).
Vediamo tali criteri nel dettaglio: - per i cibi umidi e grassi (alimenti tipo carni e prodotti di carne, formaggi, pasticceria fresca, alimenti fritti e arrostiti, ecc.) in grado di svolgere elevata azione estrattiva per le loro proprietà solventi, i materiali a contatto con l’alimento devono prevedere prove di migrazione che ne garantiscano la salubrità. La carta deve possedere elevata resistenza e impermeabilità, non deve essere riciclata e perciò deve essere costituita da almeno il 75 percento di materie fibrose, con un basso contenuto di sostanza di carica (inferiore al 10 percento) e un massimo del 15 percento di sostanze ausiliarie; - per gli alimenti secchi (pane, pasticceria secca, ortaggi e frutta, spezie e piante aromatiche, ecc.) per i quali non sono previste prove di migrazione, perché stabili e con basso potere estrattivo, si possono usare fibre di recupero con un contenuto totale di fibra superiore al 60 percento di materie fibrose, le sostanze
di carica possono arrivare al massimo al 25 percento, con un 15 percento massimo di sostanze ausiliarie.
Per mettere in evidenza che i materiali e oggetti destinati a entrare a contatto con gli alimenti sono idonei e rispettano i requisiti di salubrità e sicurezza definiti dal regolamento (CE) n. 1935/2004, i produttori di MOCA devono riportare la dicitura “per contatto con i prodotti alimentari” o usare il pittogramma indicante bicchiere e forchetta, oppure nel caso di utilizzo specifico dell’articolo devono menzionare per quale tipo di prodotto quel materiale va usato. Per garantire il corretto smaltimento dei materiali, specie di quelli accoppiati, in conformità con l’etichettatura ambientale, possono essere riportate le informazioni di smaltimento per le rispettive raccolte, spesso accompagnate da una simbologia costituita da tre frecce sottili a formare un triangolo, al cui interno può essere inserito un numero e/o una sigla che corrisponde al tipo di materiale usato per l’imballaggio. Il simbolo da solo tuttavia non fornisce specifiche sulla riciclabilità della confezione ma segnala il tipo di materiale utilizzato per produrlo di modo che, sapendo interpretare le sigle (ci sono ormai numerose tabelle predefinite che si
trovano in internet), sia facile capire come smaltirlo.
A ulteriore corredo della sicurezza dei materiali del packaging, occorre considerare da ultimo che il regolamento europeo e la legislazione italiana prevedono che sia il produttore di MOCA a fornire un certificato di idoneità dei materiali di imballaggi: queste verifiche possono essere condotte dall’operatore economico medesimo oppure essere affidate a laboratori specializzati o ancora ad organismi di certificazione, in grado di rilasciare una garanza di conformità, verificata da un organismo di terza parte.
È invece compito degli operatori del settore alimentare (OSA), cioè il responsabile di un’azienda alimentare o della distribuzione o chi acquista i materiali del packaging usati per confezionare e/o distribuire gli alimenti, di provvedere a richiedere e ad accompagnare ciò che si acquista con documentazione tecnica che ne attesti l’idoneità all’uso alimentare. Questa documentazione deve essere fornita dal produttore del materiale e deve contene-
re informazioni sulla composizione, sulla conformità alle normative e sui test di sicurezza effettuati. Sta all’OSA tenere traccia di queste informazioni e archiviare la documentazione in caso di eventuali controlli da parte delle autorità competenti, nonché di richiedere che le schede tecniche siano sempre aggiornate. È importante che le aziende alimentari e i titolari di esercizi commerciali si assicurino che i fornitori dei materiali di packaging siano certificati e rispettino le normative e le direttive in materia di sicurezza e idoneità all’uso alimentare. È consigliabile inoltre effettuare regolari controlli di qualità sui materiali ricevuti per garantire la loro conformità e sicurezza.
È evidente che non solo i produttori di MOCA devono essere sempre informati sulle normative e i regolamenti riguardanti il packaging alimentare, ma anche gli OSA che utilizzano il packaging devono avere le medesime attenzioni, così da scegliere materiali adeguati al tipo di alimento da confezionare, in grado di garantirne la freschezza e l’integrità.


Per richiedere l’abbonamento compilare il modulo online sul sito
in alternativa inviare una e-mail a abbonamenti@ecod.it riportando tutti i dati necessari per il corretto recapito della rivista
Le modalità di pagamento verranno comunicate a seguito del ricevimento della richiesta L’abbonamento può essere sottoscritto in qualsiasi giorno dell’anno e vale per i 6 numeri successivi. L’abbonamento partirà a pagamento avvenuto.
Per maggiori info scrivere a: abbonamenti@ecod.it Ecod Srl - Tel. 0331518056

UNA QUESTIONE CONTROVERSA, UN DIBATTITO NECESSARIO
UN GRAZIE DALL’EDITORE
Si è svolto, lo scorso mese di aprile, a MalpensaFiere, il forum Meat Experience organizzato dalla nostra casa editrice Ecod. In quell’occasione abbiamo avuto l’onore di ospitare un congresso, a cura di Federcarni, che ha analizzato uno dei temi più d’attualità del momento. Con grande piacere ne diamo riscontro ai lettori su queste pagine, certi del loro interesse, e ringraziamo Federcani per l’amicizia e la collaborazione che da molti anni legano le nostre realtà, così come ringraziamo tutti coloro che, con entusiasmo, hanno partecipato al forum dimostrando che l’impegno da tutti profuso è compreso e apprezzato.
Luca Codato
Tutelare una delle attività antropiche più radicate nella Storia o aprirsi alle nuove tecnologie per far fronte alle esigenze di una popolazione in aumento e di un ambiente in sofferenza? Se ne è parlato durante il Forum Meat Experience, in compagnia di ricercatori ed esperti del settore carni.
NUOVE FRONTIERE
DELLA CARNE E UN’OCCASIONE PER FARE IL PUNTO
La produzione e la lavorazione delle carni sono attività fondamentali nel nostro Paese, sia dal punto di vista economico sia per quanto riguarda gli aspetti culturali e tradizionali ad esse legati. Eppure, alla luce delle crescenti problematiche ambientali e allo sviluppo di nuovi metodi hi-tech per sgravare l’ecosistema dall’attività umana pur continuando a soddisfare in modo più sostenibile le richieste di una popolazione in crescita,
anche l’Italia è costretta a confrontarsi con tematiche controverse come l’avvento della cosiddetta “carne coltivata” o “cell culturedelivered meat”.
NON CHIAMIAMOLA
“CARNE SINTETICA”
Come ha sottolineato nell’apertura del suo intervento la Dott.ssa Federica Cheli (Prof. Ordinario di Nutrizione e Alimentazione Animale, Dipartimento di Medicina Veterinaria e Scienze Animali, Università degli Studi di Milano), «le definizioni e la comunicazione contano, e parlare di “carne sintetica” è fuorviante» oltre che tecnicamente scorretto. Infatti «la “carne coltivata” deriva dalla cosiddetta “agricoltura cellulare” (espressione coniata nel 2015, ndr), ovvero dalla tecnologia che sfrutta la possibilità di far crescere tessuti animali o vegetali all’interno di bioreattori, a partire da vere cellule, nutrite con ormoni naturali». Già utilizzata dalla medicina rigenerativa, questa tecnologia è oggetto d’in-

Intervenuto da remoto: Francesco LollobrigidaMinistro dell’Agricoltura, della Sovranità Alimentare e delle Foreste
teresse da parte dell’industria alimentare più avveniristica dal 2013, quando il dott. Mark Post di Moosa Meat ha realizzato il primo hamburger coltivato in laboratorio. E oggi persino la NASA ne sta valutando le possibili applicazioni per coltivare alimenti in condizioni estreme, ricreando ambienti controllati e favorevoli alla riproduzione cellulare.
CARNE “COLTIVATA”:
METODO E VANTAGGI
Il processo di “coltivazione” della carne avviene in più fasi, durante le quali le cellule (staminali) vengono
1. selezionate e prelevate dall’animale mediante biopsie non invasive
2. fatte crescere in laboratorio, in ambiente controllato
3. differenziate tra muscolari e adipose
4. fatte riprodurre su appositi supporti (o “impalcature”) detti scaffold in modo da ottenere un tessuto tridimensionale e con la giusta percentuale di grasso.
«Il risultato è una carne dalla texture ottimale e con buone caratteristiche organolettiche, di cui è garantita la sicurezza lungo tutta la filiera e per la quale, grazie all’ambiente controllato di crescita, sono esclusi rischi di contaminazione microbica» spiega la Professoressa Cheli.
Per quanto riguarda gli aspetti nutrizionali, infine «ci sono ancora pochi raffronti rispetto alla “vera carne”, ma non è esclusa la possibilità di ottenere con questo metodo alimenti “sartoriali”, che non solo ricalchino i vantaggi della carne tradizionale (in termini di contenuto di ferro e sostanze bioattive utili, ndr), ma siano formulati in modo da poter rispondere a esigenze specifiche» per esempio differenziando tra carne destinata agli sportivi, ai bambini, agli anziani, eccetera».
CARNE “COLTIVATA” VS “TRADIZIONALE”: CONCORRENZA O POSSIBILE CONVIVENZA?
La “carne coltivata” rappresenta attualmente un novel food diverso rispetto alla carne come finora l’abbiamo conosciuta, ma non sostitutivo ad essa; il frutto di una nuova frontiera della ricerca resa necessaria dal bisogno di produrre alimenti per una popolazione in crescita, in modo etico e sostenibile. Tuttavia anch’essa è tuttora oggetto di una ricerca multidisciplinare e transdisciplinare che ha lo scopo di valutarne l’impatto sull’ambiente e, almeno per il prossimo futuro, non rappresenta un’alternativa in grado di contrapporsi

alla vera carne, alla quale si legano aspetti culturali atavici, tradizioni millenarie e interessi economici consolidati, cui difficilmente l’umanità sarà disposta a rinunciare.
ASPETTI NORMATIVI
A rendere ancora più improbabile la prossima sostituzione della “carne coltivata” a quella proveniente da animali allevati è l’assetto legislativo. Come sottolinea il Dottor Felice Adinolfi (Professore Ordinario di Economia Agraria ed Estimo Rurale, Dipartimento di Scienze Mediche Veterinarie dell’Università Alma Studiorum di Bologna), «attualmente, dal punto di vista normativo, la “carne coltivata” non esiste», ovvero non c’è una disciplina unitaria che ne determini universalmente i criteri di sicurezza né le condizioni di immissione sul mercato. «Ad oggi le uniche autorizzazioni concesse riguardano singoli prodotti, di singoli brand, con singoli brevetti (dai nugget di pollo della start up di

San Francisco Eat Just, ammessa alla vendita al pubblico dalla Singapore Food Agency nel 2019 alle bistecche di Black Angus della startup Aleph Farms, approvate a inizio anno dal Ministero della Salute israeliano): non esiste cioè un quadro normativo applicabile all’intero comparto» e neppure a prodotti simili tra loro, dello stesso marchio o di marchi diversi.
Dal canto suo la Commissione Europea non ha ancora ricevuto alcuna richiesta di approvazione per la messa in commercio sul mercato comunitario di prodotti a base di carne coltivata, ma Paesi come Italia, Francia e Austria hanno cominciato a lavorare ai presupposti perché ciò possa avvenire in futuro, innanzitutto chiedendo all’EFSA di adottare nei confronti di questo novel food una disciplina diversa da quella - estremamente rigida e più restrittiva rispetto ad altre nazioni - applicata al cibo tradizionale.
INVESTIMENTI,
Sugli aspetti economici connessi alla carne coltivata come fonte alternativa di proteine si è espresso il Prof. Paolo Sckokai (Professore ordinario e Direttore del Dipartimento di economia agroalimentare dell’Università Cattolica del Sacro Cuore di Piacenza): «Nei prossimi 10 anni si prevede un aumento della domanda di carni dell’1% all’anno, per effetto tanto dell’aumento della popolazione mondiale, quanto del consumo pro-capite, soprattutto nei Paesi emergenti e a basso reddito». La risposta più immediata da parte dei produttori sarà l’aumento degli allevamenti in aree del mondo in via di sviluppo come Cina, India e Sudamerica. E questo permetterà ai prezzi della carne di mantenersi stabili. «Va da sé che, per avere successo sul merca-
to, la carne coltivata dovrebbe riuscire a essere messa in commercio allo stesso prezzo di quella tradizionale, laddove attualmente costa 63 dollari al kg a causa della difficoltà a passare dalla fase sperimentale di laboratorio a quella industriale, con impianti di produzione in grado di mettere in atto economie di scala in grado di far scendere il prezzo a 17-35 dollari al kg». Questa difficoltà, insieme agli ostacoli normativi e alla difficoltà di valutare il posizionamento della carne coltivata sul mercato e di individuarne i canali distributivi più strategici, è alla base della recente inversione di rotta degli investimenti economici in questo settore che, dopo essere cresciuti dal 2013 al 2020, hanno cominciato a decrescere.
Per risollevare le sorti del comparto serve il sostegno di realtà come EIT Food (European Institute of Innovation and Technology), una community che riunisce gli stakeholder del settore e che, con il finanziamento dell’UE, sostiene programmi di sviluppo, sostegno delle start up, divulgazione e coinvolgimento dell’opinione pubblica in merito al tema della diversificazione proteica (carne coltivata ma anche proteine derivanti da fonti vegetali, insetti e alghe).
COME RENDERE APPETIBILE
LA CARNE COLTIVATA
IN UN FUTURO (PIÙ O MENO)
PROSSIMO?
Fare previsioni sul mercato della carne coltivata è difficile perché, come sottolinea il Prof. Sckokai, «ad oggi non esistono ampi studi che indaghino le ipotesi di scelta dei consumatori posti di fronte alla possibilità reale di acquistare carne coltivata al supermercato». Ci sono però alcuni sondaggi secondo i quali il numero di persone disponibili a provare questo novel food sarebbe in crescita rispetto ad alcuni anni fa, soprattutto in virtù dei vantaggi ambientali di questo tipo di scelta di consumo. «Pertanto, per rendere commercialmente “appetibile” la carne coltivata e far sì che i consumatori siano disposti a spendere di più per acquistarla, bisogna puntare


sull’aspetto ecologico, ovvero investire per comunicare il concetto di “transizione verde”» che l’avvento della proteine alternative può contribuire ad accelerare, consentendo di ridurre le emissioni di gas metano e la deforestazione connesse agli allevamenti intensivi e i loro effetti disastrosi sul cambiamento climatico.
In più, altri aspetti su cui il settore della “cell culture - delivered meat” dovrà puntare sono la maggiore eticità del processo produttivo (per esempio eliminando il ricorso al siero fetale bovino e puntando su naturali meccanismi di chimica pulita come la fotosintesi per nutrire le cellule) e il miglioramento della texture e delle caratteristiche organolettiche del prodotto (nella consapevolezza che coltivare una bistecca è molto diverso da ottenere un hamburger).
IL RUOLO DEL SETTORE DELLA
CARNE TRADIZIONALE E LA POSIZIONE DI FEDERCARNI
Consapevole che il percorso verso il Green Deal è ormai avviato (come dimostrano la legge europea sul clima del luglio 2021 e l’impegno dell’UE a conseguire la decarbonizzazione o “neutralità climatica” entro il 2050), anche il settore della carne tradizionale ha iniziato ad adeguarsi, e sempre più aziende compiono grandi sforzi (tecnologici, economici e di ricerca) per adeguarsi al cambiamento, riducendo le emissioni di gas serra, il consumo di acqua e di antibiotici, autoproducendo i mangimi destinati agli animali e rinunciando a concentrare gli allevamenti in territori incapaci di assorbirne gli effetti
ecologici.
Da parte sua Federcarni, da sempre impegnata (insieme a Confagricoltura) a garantire la sicurezza dei consumatori attraverso il controllo sulla qualità dei prodotti immessi sul mercato, ma anche a tutelare l’artigianalità dei professionisti della carne, vuole anticipare il cambiamento verso una sostenibilità in cui scienza ed economia possano viaggiare su binari paralleli, accettando l’idea che l’artigianalità dei professionisti della carne si armonizzi con le nuove norme e le nuove scoperte. Per questo ha promosso un “patto di trasparenza” tra gli operatori della filiera, con lo scopo di garantire il rispetto del benessere animale, la sostenibilità ambientale ed economica dell’attività per tutti gli operatori del settore (circa 200 mila aziende, tra cui molti piccoli produttori), nonché la permanenza degli aspetti culturali del cibo italiano, che si legano anche alle sue tecniche produttive tradizionali nonché ai canali distributivi “di prossimità” (come il negozio di quartiere e la piccola bottega).
L’obiettivo? Far sì che gli artigiani della zootecnia italiana possano svolgere il loro mestiere in modo tradizionale e al tempo stesso nuovo, etico e sostenibile, sfruttando nuove sinergie e con un’apertura verso il futuro che porti a interpretare esigenze, trend, gusti e mode diversi da quelli di 10 anni fa. Solo in questo modo le sfide possono trasformarsi in opportunità, a prescindere dal peso che la carne coltivata avrà sulle abitudini di consumo del prossimo futuro.



Progettiamo e costruiamo impianti frigoriferi ad alta tecnologia utilizzando l’ammoniaca come refrigerante.
I nostri prodotti garantiscono risparmio energetico, efficienza, sicurezza e rispondono ad elevati standard di automazione.
La refrigerazione all’avanguardia. Affidabile, ecologica, economica.
www.zudek.com sales@zudek.com